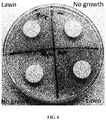

EP3492094A1 - Administration of kynurenine depleting enzymes for tumor therapy - Google Patents
Administration of kynurenine depleting enzymes for tumor therapy Download PDFInfo
- Publication number
- EP3492094A1 EP3492094A1 EP18204264.8A EP18204264A EP3492094A1 EP 3492094 A1 EP3492094 A1 EP 3492094A1 EP 18204264 A EP18204264 A EP 18204264A EP 3492094 A1 EP3492094 A1 EP 3492094A1
- Authority
- EP
- European Patent Office
- Prior art keywords
- enzyme
- kynureninase
- cell
- kynurenine
- peg
- Prior art date
- Legal status (The legal status is an assumption and is not a legal conclusion. Google has not performed a legal analysis and makes no representation as to the accuracy of the status listed.)
- Withdrawn
Links
Images
Classifications
-
- A—HUMAN NECESSITIES
- A61—MEDICAL OR VETERINARY SCIENCE; HYGIENE
- A61K—PREPARATIONS FOR MEDICAL, DENTAL OR TOILETRY PURPOSES
- A61K35/00—Medicinal preparations containing materials or reaction products thereof with undetermined constitution
- A61K35/12—Materials from mammals; Compositions comprising non-specified tissues or cells; Compositions comprising non-embryonic stem cells; Genetically modified cells
- A61K35/14—Blood; Artificial blood
- A61K35/17—Lymphocytes; B-cells; T-cells; Natural killer cells; Interferon-activated or cytokine-activated lymphocytes
-
- A—HUMAN NECESSITIES
- A61—MEDICAL OR VETERINARY SCIENCE; HYGIENE
- A61K—PREPARATIONS FOR MEDICAL, DENTAL OR TOILETRY PURPOSES
- A61K38/00—Medicinal preparations containing peptides
- A61K38/16—Peptides having more than 20 amino acids; Gastrins; Somatostatins; Melanotropins; Derivatives thereof
- A61K38/43—Enzymes; Proenzymes; Derivatives thereof
- A61K38/46—Hydrolases (3)
-
- A—HUMAN NECESSITIES
- A61—MEDICAL OR VETERINARY SCIENCE; HYGIENE
- A61K—PREPARATIONS FOR MEDICAL, DENTAL OR TOILETRY PURPOSES
- A61K40/00—Cellular immunotherapy
- A61K40/40—Cellular immunotherapy characterised by antigens that are targeted or presented by cells of the immune system
- A61K40/41—Vertebrate antigens
- A61K40/42—Cancer antigens
- A61K40/4244—Enzymes
-
- A—HUMAN NECESSITIES
- A61—MEDICAL OR VETERINARY SCIENCE; HYGIENE
- A61P—SPECIFIC THERAPEUTIC ACTIVITY OF CHEMICAL COMPOUNDS OR MEDICINAL PREPARATIONS
- A61P35/00—Antineoplastic agents
-
- A—HUMAN NECESSITIES
- A61—MEDICAL OR VETERINARY SCIENCE; HYGIENE
- A61P—SPECIFIC THERAPEUTIC ACTIVITY OF CHEMICAL COMPOUNDS OR MEDICINAL PREPARATIONS
- A61P43/00—Drugs for specific purposes, not provided for in groups A61P1/00-A61P41/00
-
- C—CHEMISTRY; METALLURGY
- C12—BIOCHEMISTRY; BEER; SPIRITS; WINE; VINEGAR; MICROBIOLOGY; ENZYMOLOGY; MUTATION OR GENETIC ENGINEERING
- C12N—MICROORGANISMS OR ENZYMES; COMPOSITIONS THEREOF; PROPAGATING, PRESERVING, OR MAINTAINING MICROORGANISMS; MUTATION OR GENETIC ENGINEERING; CULTURE MEDIA
- C12N15/00—Mutation or genetic engineering; DNA or RNA concerning genetic engineering, vectors, e.g. plasmids, or their isolation, preparation or purification; Use of hosts therefor
- C12N15/09—Recombinant DNA-technology
- C12N15/11—DNA or RNA fragments; Modified forms thereof; Non-coding nucleic acids having a biological activity
- C12N15/52—Genes encoding for enzymes or proenzymes
-
- C—CHEMISTRY; METALLURGY
- C12—BIOCHEMISTRY; BEER; SPIRITS; WINE; VINEGAR; MICROBIOLOGY; ENZYMOLOGY; MUTATION OR GENETIC ENGINEERING
- C12N—MICROORGANISMS OR ENZYMES; COMPOSITIONS THEREOF; PROPAGATING, PRESERVING, OR MAINTAINING MICROORGANISMS; MUTATION OR GENETIC ENGINEERING; CULTURE MEDIA
- C12N9/00—Enzymes; Proenzymes; Compositions thereof; Processes for preparing, activating, inhibiting, separating or purifying enzymes
- C12N9/14—Hydrolases (3)
-
- C—CHEMISTRY; METALLURGY
- C12—BIOCHEMISTRY; BEER; SPIRITS; WINE; VINEGAR; MICROBIOLOGY; ENZYMOLOGY; MUTATION OR GENETIC ENGINEERING
- C12N—MICROORGANISMS OR ENZYMES; COMPOSITIONS THEREOF; PROPAGATING, PRESERVING, OR MAINTAINING MICROORGANISMS; MUTATION OR GENETIC ENGINEERING; CULTURE MEDIA
- C12N9/00—Enzymes; Proenzymes; Compositions thereof; Processes for preparing, activating, inhibiting, separating or purifying enzymes
- C12N9/96—Stabilising an enzyme by forming an adduct or a composition; Forming enzyme conjugates
-
- C—CHEMISTRY; METALLURGY
- C12—BIOCHEMISTRY; BEER; SPIRITS; WINE; VINEGAR; MICROBIOLOGY; ENZYMOLOGY; MUTATION OR GENETIC ENGINEERING
- C12Y—ENZYMES
- C12Y307/00—Hydrolases acting on carbon-carbon bonds (3.7)
- C12Y307/01—Hydrolases acting on carbon-carbon bonds (3.7) in ketonic substances (3.7.1)
- C12Y307/01003—Kynureninase (3.7.1.3)
-
- A—HUMAN NECESSITIES
- A61—MEDICAL OR VETERINARY SCIENCE; HYGIENE
- A61K—PREPARATIONS FOR MEDICAL, DENTAL OR TOILETRY PURPOSES
- A61K2121/00—Preparations for use in therapy
-
- A—HUMAN NECESSITIES
- A61—MEDICAL OR VETERINARY SCIENCE; HYGIENE
- A61K—PREPARATIONS FOR MEDICAL, DENTAL OR TOILETRY PURPOSES
- A61K2300/00—Mixtures or combinations of active ingredients, wherein at least one active ingredient is fully defined in groups A61K31/00 - A61K41/00
-
- A—HUMAN NECESSITIES
- A61—MEDICAL OR VETERINARY SCIENCE; HYGIENE
- A61K—PREPARATIONS FOR MEDICAL, DENTAL OR TOILETRY PURPOSES
- A61K38/00—Medicinal preparations containing peptides
Definitions
- the invention generally relates to compositions and methods for the treatment of cancer with enzymes that deplete L-kynurenine or L-3-hydroxykynurenine. More particularly, it concerns the engineering, pharmacological optimization and use of bacterial and mammalian enzymes with L-kynurenine degrading activity suitable for human therapy.
- IDO1 or IDO2 indolamine-2,3-dioxygenase isoforms
- TDO tryptophan 2,3-dioxygenase
- Tumors exchange a cytosolic KYN molecule for an extracellular Trp molecule using a LAT1-like amino acid exchanger (Kaper et al., 2007), which has the dual effect on immune cells of locally elevating levels of KYN while locally depleting Trp levels.
- AHR aryl hydrocarbon receptor
- KYN-related compounds formed from kynurenine most notably kynurenic acid also exert an immunosuppressive effect by serving as agonists of the orphan GPCR GPCR35.
- Inhibition of KYN formation and thus inhibition of the formation of KYN metabolism byproducts, including kynurenic acid, 3-hydroxyl kynurenine and quinolinic acid, via the inhibition of IDO1 or TDO has received a significant amount of attention as a cancer target (Chen and Guillemin, 2009; Rutella et al., 2009; Prendergast, 2011).
- Substrate analog inhibitors such as 1-DL-methyltryptophan, for IDO1 have been developed and have shown initial promise in overcoming cancer induced tumor tolerance thus restoring the ability of the native immune system to fight tumors (Lob et al., 2009).
- KYN is also produced by tryptophan 2,3-dioxygenase (TDO), which is also frequently expressed in tumors and this enzyme is not inhibited by 1-DL-methyltryptophan (Pilotte et al., 2012).
- TDO tryptophan 2,3-dioxygenase
- 1-DL-methyltryptophan 1-DL-methyltryptophan
- 1-D-MT D-isomer of 1-DL-methyltryptophan
- 1-D-MT can upregulate IDO1 expression, actually increasing KYN levels and inducing immunosuppression in certain cancers (Opitz et al., 2011).
- KYN is a potent ligand of the aryl hydrocarbon receptor (AHR) whose activation in T cells induces differentiation into CD25+FoxP3+ T regulatory cells (Tregs) (Mezrich et al., 2010).
- AHR aryl hydrocarbon receptor
- KYN has also been shown to prevent cytokine mediated up-regulation of specific receptors (NKp46 and NKG2D) required for NK mediated cell killing tumor cell lines (Della Chiesa et al., 2006), an action that is also likely mediated by its agonistic effect on AHR (Shin et al., 2013).
- NKp46 and NKG2D specific receptors
- AHR agonistic effect on AHR
- IDO inhibitors such as 1-D-MT
- 1-D-MT small molecule IDO inhibitors
- the present invention discloses the use enzymes for the specific depletion of KYN and its metabolites in tumors and/or in the blood.
- KYN depleting enzymes are used to lower KYN concentrations for the treatment of tumors expressing IDO1, IDO2, or TDO thus preventing tumor-mediated tolerogenic effects and instead mediating tumor-ablating pro-inflammatory responses.
- the use of enzymes for the depletion of KYN and KYN metabolic byproducts circumvents the problems associated with small molecule inhibitors of IDO isoforms and TDO discussed above and further completely circumvents off target effects that are very commonly accompany small molecule drugs and lead to unpredicted toxicities and side effects.
- aspects of the present invention overcome a major deficiency in the art by providing enzymes that comprise bacterial and mammalian polypeptide sequences capable of degrading L-kynurenine and 3-hydroxy-L-kynurenine and displaying favorable pharmacokinetics in serum as desired for cancer therapy.
- the kynureninase enzyme may have greater catalytic activity towards kynurenine than 3'OH-kynurenine.
- a kynureninase from a bacterial species may be used.
- Such an enzyme may have an amino acid sequence selected from the group consisting of SEQ ID NOs: 7 and 13-52 or a modified version thereof.
- the therapeutic may be derived from the Pseudomonas fluorescens enzyme, kynureninase ( Pf -KYNU).
- kynureninase from Saccharomyces cerevisiae or Neurospora crassa may be used.
- the therapeutic may be derived from the Mucilaginibacter paludis kynureninase enzyme.
- the Homo sapiens enzyme or other primate kynureninases displaying >95% sequence identity to the human enzyme may be used.
- a novel enzyme may have an amino acid sequence selected from the group consisting of SEQ ID NOs: 7-9.
- polypeptide comprising either a native or modified human or primate kynureninase capable of degrading KYN and having activity towards the degradation of 3-hydroxykynurenine or kynurenic acid.
- the polypeptide may be capable of degrading KYN under physiological conditions.
- the polypeptide may have a catalytic efficiency for KYN ( k cat / K M ) of at least or about 0.01, 0.05, 0.1, 0.2, 0.3, 0.4, 0.5, 0.6, 0.7, 0.8, 0.9, 1, 2, 3, 4, 5, 6, 7, 8, 9, 10, 20, 30, 40, 50, 60, 70, 80, 90, 100, 200, 300, 400, 500, 600, 700, 800, 900, 1000, 2000, 3000, 4000, 5000, 6000, 7000, 8000, 9000, 10 4 , 10 5 , 10 6 M -1 s -1 or any range derivable therein.
- KYN k cat / K M
- a modified polypeptide as discussed above may be characterized as having a certain percentage of identity as compared to an unmodified polypeptide (e.g., a native polypeptide) or to any polypeptide sequence disclosed herein.
- the unmodified polypeptide may comprise at least, or up to, about 150, 200, 250, 300, 350, 400 residues (or any range derivable therein) of a native kynureninase.
- the percentage identity may be about, at most or at least 40%, 50%, 55%, 60%, 65%, 70%, 75%, 80%, 85%, 90%, 95%, 96%, 97%, 98%, 99% or 100% (or any range derivable therein) between the modified and unmodified polypeptides, or between any two sequences in comparison. It is also contemplated that percentage of identity discussed above may relate to a particular modified region of a polypeptide as compared to an unmodified region of a polypeptide.
- a polypeptide may contain a modified or mutant substrate recognition site of a kynureninase that can be characterized based on the identity of the amino acid sequence of the modified or mutant substrate recognition site of the kynureninase to that of an unmodified or mutant kynureninase from the same species or across the species.
- a modified or mutant human polypeptide characterized, for example, as having at least 90% identity to an unmodified kynureninase means that at least 90% of the amino acids in that modified or mutant human polypeptide are identical to the amino acids in the unmodified polypeptide.
- Such an unmodified polypeptide may be a native kynureninase, particularly a human isoform or other primate isoforms.
- the native human kynureninase may have the sequence of SEQ ID NO: 8.
- Non-limiting examples of other native primate kynureninase include Pongo abelii kynureninase (Genbank ID: XP_002812508.1; SEQ ID NO: 10), Macaca fascicularis kynureninase (Genbank ID: EHH54849.1; SEQ ID NO: 11), and Pan troglodytes kynureninase (Genbank ID: XP_003309314.1; SEQ ID NO: 12).
- Exemplary native polypeptides include a sequence having about, at most or at least 50%, 55%, 60%, 65%, 70%, 75%, 80%, 85%, 90%, 95%, 96%, 97%, 98%, 99% or 100% identity (or any range derivable therein) of SEQ ID NO: 8 or 10-12 or a fragment thereof.
- the native polypeptide may comprise at least or up to about 10, 20, 30, 40, 50, 60, 70, 80, 90, 100, 150, 200, 250, 300, 350, 400, 415 residues (or any range derivable therein) of the sequence of SEQ ID NO: 8 or 10-12.
- the native kynureninase may be modified by one or more other modifications, such as chemical modifications, substitutions, insertions, deletions, and/or truncations.
- the modifications may be at a substrate recognitions site of the native enzyme.
- the native kynureninase may be modified by substitutions.
- the number of substitutions may be one, two, three, four or more.
- the native kynureninase may be modified in the substrate recognition site or any location that may affect substrate specificity.
- an isolated, modified human kynureninase enzyme wherein the modified enzyme has at least one substitution relative to native human kynureninase (see SEQ ID NO: 8), and wherein the at least one substitution includes a Met or Leu substitution for a Phe normally found at position 306 of native human kynureninase.
- an isolated, modified human kynureninase enzyme is provided that comprises a Phe306Met substitution.
- an isolated, modified human kynureninase enzyme is provided that comprises a Phe306Leu substitution.
- the present invention also contemplates polypeptides comprising a kynureninase linked to a heterologous amino acid sequence.
- the kynureninase may be linked to the heterologous amino acid sequence as a fusion protein.
- the kynureninase may be linked to amino acid sequences, such as an IgG Fc, albumin, an albumin binding protein, or an XTEN polypeptide for increasing the in vivo half-life.
- the kynureninase may be linked to one or more polyether molecules.
- the polyether may be polyethylene glycol (PEG).
- the polypeptide may be linked ( e.g., covalently) to PEG via specific amino acid residues, such as lysine or cysteine.
- PEG polyethylene glycol
- such a polypeptide comprising the kynureninase may be dispersed in a pharmaceutically acceptable carrier.
- a nucleic acid encoding such a kynureninase is contemplated.
- the nucleic acid has been codon optimized for expression in bacteria.
- the bacteria is E. coli.
- the nucleic acid has been codon optimized for expression in fungus (e.g., yeast), insects, or mammals.
- the present invention further contemplates vectors, such as expression vectors, containing such nucleic acids.
- the nucleic acid encoding the kynureninase is operably linked to a promoter, including but not limited to heterologous promoters.
- a kynureninase may be delivered to a target cell by a vector (e.g., a gene therapy vector).
- viruses may have been modified by recombinant DNA technology to enable the expression of the kynureninase-encoding nucleic acid in the target cell.
- These vectors may be derived from vectors of non-viral (e.g., plasmids) or viral (e.g., adenovirus, adeno-associated virus, retrovirus, lentivirus, herpes virus, or vaccinia virus) origin.
- Non-viral vectors are preferably complexed with agents to facilitate the entry of the DNA across the cellular membrane. Examples of such non-viral vector complexes include the formulation with polycationic agents which facilitate the condensation of the DNA and lipid-based delivery systems.
- An example of a lipid-based delivery system would include liposome based delivery of nucleic acids.
- the present invention further contemplates host cells comprising such vectors.
- the host cells may be bacteria (e.g., E. coli ), fungal cells (e.g., yeast), insect cells, or mammalian cells.
- the vectors are introduced into host cells for expressing the kynureninase.
- the proteins may be expressed in any suitable manner. In one embodiment, the proteins are expressed in a host cell such that the protein is glycosylated. In another embodiment, the proteins are expressed in a host cell such that the protein is aglycosylated.
- Certain aspects of the present invention also contemplate methods of treatment by the administration of the kynureninase peptide, the nucleic acid encoding the kynureninase in a gene therapy vector, or the formulation of the present invention, and in particular methods of treating tumor cells or subjects with cancer.
- the subject may be any animal, such as a mouse.
- the subject may be a mammal, particularly a primate, and more particularly a human patient.
- the method may comprise selecting a patient with cancer.
- the cancer is any cancer that is sensitive to kynurenine depletion.
- the present invention contemplates a method of treating a tumor cell or a cancer patient comprising administering a formulation comprising such a polypeptide.
- the administration occurs under conditions such that at least a portion of the cells of the cancer are killed.
- the formulation comprises such a kynureninase with kynurenine-degrading activity at physiological conditions and further comprising an attached polyethylene glycol chain.
- the formulation is a pharmaceutical formulation comprising any of the above discussed kynureninases and pharmaceutically acceptable excipients. Such pharmaceutically acceptable excipients are well known to those of skill in the art. All of the above kynureninases may be contemplated as useful for human therapy.
- a method of treating a tumor cell comprising administering a formulation comprising a non-bacterial (mammalian, e.g., primate or mouse) kynureninase that has kynurenine-degrading activity or a nucleic acid encoding thereof.
- a formulation comprising a non-bacterial (mammalian, e.g., primate or mouse) kynureninase that has kynurenine-degrading activity or a nucleic acid encoding thereof.
- treating a tumor cell includes contacting the nutrient medium for a population of tumor cells with the kynureninase.
- the medium can be blood, lymphatic fluid, spinal fluid and the like bodily fluid where kynurenine depletion is desired.
- such a formulation containing the kynureninase can be administered intravenously, intradermally, intraarterially, intraperitoneally, intralesionally, intracranially, intraarticularly, intraprostaticaly, intrapleurally, intrasynovially, intratracheally, intranasally, intravitreally, intravaginally, intrarectally, intratumorally, intramuscularly, subcutaneously, subconjunctival, intravesicularlly, mucosally, intrapericardially, intraumbilically, intraocularly, orally, topically, by inhalation, infusion, continuous infusion, localized perfusion, via a catheter, via a lavage, in lipid compositions ( e.g ., liposomes), or by other method or any combination of the forgoing as would be known to one of ordinary skill in the art.
- lipid compositions e.g ., liposomes
- the method may also comprise administering at least a second anticancer therapy to the subject.
- the second anticancer therapy may be a surgical therapy, chemotherapy, radiation therapy, cryotherapy, hormone therapy, immunotherapy or cytokine therapy.
- the second anticancer therapy may be an anti-PD-1, anti-CTLA-4, or anti- PD-L1 antibody.
- a cell comprising a chimeric antigen receptor (CAR) and a kynureninase enzyme are contemplated for use in treating a subject with cancer.
- the cell may be transfected with a DNA encoding the CAR and the kynureninase and, in some cases, a transposase.
- the CAR may target any cancer-cell antigen of interest, including, for example, HER2, CD19, CD20, and GD2.
- the antigen binding regions or domain can comprise a fragment of the V H and V L chains of a single-chain variable fragment (scFv) derived from a particular human monoclonal antibody, such as those described in U.S. Patent 7,109,304 , which is incorporated herein by reference in its entirety.
- the fragment can also be any number of different antigen binding domains of a human antigen-specific antibody.
- the fragment is an antigen-specific scFv encoded by a sequence that is optimized for human codon usage for expression in human cells.
- CARs see, for example, WO 2012/031744 , WO 2012/079000 , WO 2013/059593 , and U.S. Patent 8,465,743 , all of which are incorporated herein by reference in their entireties.
- the kynureninase may be any kynureninase disclosed herein.
- Methods of transfecting of cells are well known in the art, but in certain aspects, highly efficient transfections methods such as electroporation are employed.
- nucleic acids may be introduced into cells using a nucleofection apparatus.
- the transfection step does not involve infecting or transducing the cells with virus, which can cause genotoxicity and/or lead to an immune response to cells containing viral sequences in a treated subject.
- the CAR expression vector is a DNA expression vector such as a plasmid, linear expression vector or an episome.
- the vector comprises additional sequences, such as sequence that facilitates expression of the CAR, such a promoter, enhancer, poly-A signal, and/or one or more introns.
- the CAR coding sequence is flanked by transposon sequences, such that the presence of a transposase allows the coding sequence to integrate into the genome of the transfected cell.
- cells are further transfected with a transposase that facilitates integration of a CAR coding sequence into the genome of the transfected cells.
- the transposase is provided as DNA expression vector.
- the transposase is provided as an expressible RNA or a protein such that long-term expression of the transposase does not occur in the transgenic cells. Any transposase system may be used in accordance with the embodiments.
- cells may be infected with a lentivirus to facilitate integration of the CAR coding sequence and the kynureninase coding sequence into the genome of the cell.
- a composition comprising a kynureninase or a nucleic acid encoding a kynureninase is provided for use in the treatment of a tumor in a subject.
- the use of a kynureninase or a nucleic acid encoding a kynureninase in the manufacture of a medicament for the treatment of a tumor is provided.
- Said kynureninase may be any kynureninase of the embodiments.
- Embodiments discussed in the context of methods and/or compositions of the invention may be employed with respect to any other method or composition described herein. Thus, an embodiment pertaining to one method or composition may be applied to other methods and compositions of the invention as well.
- encode or "encoding,” with reference to a nucleic acid, are used to make the invention readily understandable by the skilled artisan; however, these terms may be used interchangeably with “comprise” or “comprising,” respectively.
- Kynurenine is a metabolite of the amino acid tryptophan generated via the action of either indolamine-2,3-dioxygenase (IDO) or tryptophan-2,3-dioxygenase (TDO). Kynurenine exerts multiple effects on cell physiology, one of the most important of which is modulation of T cell responses. Many tumor cells regulate the synthesis of IDO and/or TDO to elevate the local concentration of kynurenine, which is accompanied with depletion of tryptophan. High levels of kynurenine serve as a powerful way to inhibit the function of tumor infiltrating T cells that would otherwise attack the tumor.
- IDO indolamine-2,3-dioxygenase
- TDO tryptophan-2,3-dioxygenase
- the present invention provides methods for the use of kynurenine degrading enzymes as a means for depleting local kynurenine levels in the tumor microenvironment as well as in the serum and thus prevent tumor-mediated suppression of T-cell action.
- Kynurenine hydrolyzing enzymes (kynureninases) convert kynurenine to alanine and anthranilic acid, the latter of which is not known to affect T-cell function.
- the inventors generated a pharmaceutical preparation of kynureninase enzyme to enable the enzyme to persist for prolonged times under physiological conditions. The inventors then showed that intratumoral administration of the enzyme results in dramatic retardation of growth of an aggressive tumor in mice.
- protein and “polypeptide” refer to compounds comprising amino acids joined via peptide bonds and are used interchangeably.
- fusion protein refers to a chimeric protein containing proteins or protein fragments operably linked in a non-native way.
- half-life (1 ⁇ 2-life) refers to the time that would be required for the concentration of a polypeptide thereof to fall by half in vitro or in vivo, for example, after injection in a mammal.
- operable combination refers to a linkage wherein the components so described are in a relationship permitting them to function in their intended manner, for example, a linkage of nucleic acid sequences in such a manner that a nucleic acid molecule capable of directing the transcription of a given gene and/or the synthesis of desired protein molecule, or a linkage of amino acid sequences in such a manner so that a fusion protein is produced.
- linker is meant to refer to a compound or moiety that acts as a molecular bridge to operably link two different molecules, wherein one portion of the linker is operably linked to a first molecule, and wherein another portion of the linker is operably linked to a second molecule.
- PEGylated refers to conjugation with polyethylene glycol (PEG), which has been widely used as a drug carrier, given its high degree of biocompatibility and ease of modification.
- PEG polyethylene glycol
- PEG can be coupled ( e.g ., covalently linked) to active agents through the hydroxy groups at the end of the PEG chain via chemical methods; however, PEG itself is limited to at most two active agents per molecule.
- copolymers of PEG and amino acids have been explored as novel biomaterial that would retain the biocompatibility of PEG, but that would have the added advantage of numerous attachment points per molecule (thus providing greater drug loading), and that can be synthetically designed to suit a variety of applications.
- gene refers to a DNA sequence that comprises control and coding sequences necessary for the production of a polypeptide or precursor thereof.
- the polypeptide can be encoded by a full-length coding sequence or by any portion of the coding sequence so as the desired enzymatic activity is retained.
- native refers to the typical form of a gene, a gene product, or a characteristic of that gene or gene product when isolated from a naturally occurring source.
- a native form is that which is most frequently observed in a natural population and is thus arbitrarily designated the normal or wild-type form.
- modified refers to a gene or gene product that displays modification in sequence and functional properties ( i.e., altered characteristics) when compared to the native gene or gene product.
- vector is used to refer to a carrier nucleic acid molecule into which a nucleic acid sequence can be inserted for introduction into a cell where it can be replicated.
- a nucleic acid sequence can be "exogenous,” which means that it is foreign to the cell into which the vector is being introduced or that the sequence is homologous to a sequence in the cell but in a position within the host cell nucleic acid in which the sequence is ordinarily not found.
- Vectors include plasmids, cosmids, viruses (bacteriophage, animal viruses, and plant viruses), and artificial chromosomes (e.g ., YACs).
- plasmids include plasmids, cosmids, viruses (bacteriophage, animal viruses, and plant viruses), and artificial chromosomes (e.g ., YACs).
- YACs artificial chromosomes
- expression vector refers to any type of genetic construct comprising a nucleic acid coding for an RNA capable of being transcribed. In some cases, RNA molecules are then translated into a protein, polypeptide, or peptide. In other cases, these sequences are not translated, for example, in the production of antisense molecules or ribozymes.
- Expression vectors can contain a variety of "control sequences,” which refer to nucleic acid sequences necessary for the transcription and possibly translation of an operably linked coding sequence in a particular host cell. In addition to control sequences that govern transcription and translation, vectors and expression vectors may contain nucleic acid sequences that serve other functions as well and are described infra.
- therapeutically effective amount refers to an amount of cells and/or therapeutic composition (such as a therapeutic polynucleotide and/or therapeutic polypeptide) that is employed in methods to achieve a therapeutic effect.
- therapeutic benefit or “therapeutically effective” as used throughout this application refers to anything that promotes or enhances the well-being of the subject with respect to the medical treatment of this condition. This includes, but is not limited to, a reduction in the frequency or severity of the signs or symptoms of a disease.
- treatment of cancer may involve, for example, a reduction in the size of a tumor, a reduction in the invasiveness of a tumor, reduction in the growth rate of the cancer, or prevention of metastasis. Treatment of cancer may also refer to prolonging survival of a subject with cancer.
- K M refers to the Michaelis-Menten constant for an enzyme and is defined as the concentration of the specific substrate at which a given enzyme yields one-half its maximum velocity in an enzyme catalyzed reaction.
- k cat refers to the turnover number or the number of substrate molecules each enzyme site converts to product per unit time, and in which the enzyme is working at maximum efficiency.
- k cat / K M is the specificity constant, which is a measure of how efficiently an enzyme converts a substrate into product.
- CARs chimeric antigen receptors
- T-cell receptors may refer to artificial T-cell receptors, chimeric T-cell receptors, or chimeric immunoreceptors, for example, and encompass engineered receptors that graft an artificial specificity onto a particular immune effector cell.
- CARs may be employed to impart the specificity of a monoclonal antibody onto a T cell, thereby allowing a large number of specific T cells to be generated, for example, for use in adoptive cell therapy.
- CARs direct specificity of the cell to a tumor associated antigen, for example.
- CARs comprise an intracellular activation domain, a transmembrane domain, and an extracellular domain comprising a tumor associated antigen binding region.
- CARs comprise fusions of single-chain variable fragments (scFv) derived from monoclonal antibodies (such as those described in U.S. Patent 7,109,304 , which is incorporated herein by reference in its entirety), fused to CD3-zeta transmembrane and endodomains.
- scFv single-chain variable fragments
- the specificity of other CAR designs may be derived from ligands of receptors (e.g ., peptides) or from pattern-recognition receptors, such as Dectins.
- the spacing of the antigen-recognition domain can be modified to reduce activation-induced cell death.
- CARs comprise domains for additional co-stimulatory signaling, such as CD3-zeta, FcR, CD27, CD28, CD137, DAP10, and/or OX40.
- molecules can be co-expressed with the CAR, including co-stimulatory molecules, reporter genes for imaging (e.g., for positron emission tomography), gene products that conditionally ablate the T cells upon addition of a pro-drug, homing receptors, chemokines, chemokine receptors, cytokines, and cytokine receptors.
- co-stimulatory molecules including co-stimulatory molecules, reporter genes for imaging (e.g., for positron emission tomography), gene products that conditionally ablate the T cells upon addition of a pro-drug, homing receptors, chemokines, chemokine receptors, cytokines, and cytokine receptors.
- Treatment and “treating” refer to administration or application of a therapeutic agent to a subject or performance of a procedure or modality on a subject for the purpose of obtaining a therapeutic benefit of a disease or health-related condition.
- a treatment may include administration of a pharmaceutically effective amount of a kynureninase.
- Subject and “patient” refer to either a human or non-human, such as primates, mammals, and vertebrates. In particular embodiments, the subject is a human.
- modified proteins and polypeptides concern modified proteins and polypeptides.
- Particular embodiments concern a modified protein or polypeptide that exhibits at least one functional activity that is comparable to the unmodified version, preferably, the kynurenine degrading activity or the 3'-hydroxy-kynurenine degrading activity.
- the protein or polypeptide may be further modified to increase serum stability.
- modify protein or a "modified polypeptide”
- one of ordinary skill in the art would understand that this includes, for example, a protein or polypeptide that possesses an additional advantage over the unmodified protein or polypeptide, such as kynurenine degrading activity or 3'-hydroxy-kynurenine degrading activity.
- the unmodified protein or polypeptide is a native kynureninase, preferably a human kynureninase or the Pseudomonas fluorescens kynureninase. It is specifically contemplated that embodiments concerning a "modified protein" may be implemented with respect to a "modified polypeptide,” and vice versa.
- Determination of activity may be achieved using assays familiar to those of skill in the art, particularly with respect to the protein's activity, and may include for comparison purposes, the use of native and/or recombinant versions of either the modified or unmodified protein or polypeptide.
- a modified polypeptide such as a modified kynureninase
- a modified polypeptide may be identified based on its increase in kynurenine and/or 3'-hydroxy-kynurenine degrading activity.
- substrate recognition sites of the unmodified polypeptide may be identified. This identification may be based on structural analysis or homology analysis. A population of mutants involving modifications of such substrate recognition sites may be generated. In a further embodiment, mutants with increased kynurenine degrading activity may be selected from the mutant population. Selection of desired mutants may include methods, such as detection of byproducts or products from kynurenine degradation.
- Modified proteins may possess deletions and/or substitutions of amino acids; thus, a protein with a deletion, a protein with a substitution, and a protein with a deletion and a substitution are modified proteins. In some embodiments, these modified proteins may further include insertions or added amino acids, such as with fusion proteins or proteins with linkers, for example.
- a "modified deleted protein” lacks one or more residues of the native protein, but may possess the specificity and/or activity of the native protein.
- a "modified deleted protein” may also have reduced immunogenicity or antigenicity.
- An example of a modified deleted protein is one that has an amino acid residue deleted from at least one antigenic region that is, a region of the protein determined to be antigenic in a particular organism, such as the type of organism that may be administered the modified protein.
- Substitution or replacement variants typically contain the exchange of one amino acid for another at one or more sites within the protein and may be designed to modulate one or more properties of the polypeptide, particularly its effector functions and/or bioavailability. Substitutions may or may not be conservative, that is, one amino acid is replaced with one of similar shape and charge.
- Conservative substitutions are well known in the art and include, for example, the changes of: alanine to serine; arginine to lysine; asparagine to glutamine or histidine; aspartate to glutamate; cysteine to serine; glutamine to asparagine; glutamate to aspartate; glycine to proline; histidine to asparagine or glutamine; isoleucine to leucine or valine; leucine to valine or isoleucine; lysine to arginine; methionine to leucine or isoleucine; phenylalanine to tyrosine, leucine, or methionine; serine to threonine; threonine to serine; tryptophan to tyrosine; tyrosine to tryptophan or phenylalanine; and valine to isoleucine or leucine.
- a modified protein may possess an insertion of residues, which typically involves the addition of at least one residue in the polypeptide. This may include the insertion of a targeting peptide or polypeptide or simply a single residue. Terminal additions, called fusion proteins, are discussed below.
- biologically functional equivalent is well understood in the art and is further defined in detail herein. Accordingly, sequences that have between about 70% and about 80%, or between about 81% and about 90%, or even between about 91% and about 99% of amino acids that are identical or functionally equivalent to the amino acids of a control polypeptide are included, provided the biological activity of the protein is maintained.
- a modified protein may be biologically functionally equivalent to its native counterpart in certain aspects.
- amino acid and nucleic acid sequences may include additional residues, such as additional N- or C-terminal amino acids or 5' or 3' sequences, and yet still be essentially as set forth in one of the sequences disclosed herein, so long as the sequence meets the criteria set forth above, including the maintenance of biological protein activity where protein expression is concerned.
- the addition of terminal sequences particularly applies to nucleic acid sequences that may, for example, include various non-coding sequences flanking either of the 5' or 3' portions of the coding region or may include various internal sequences, i.e., introns, which are known to occur within genes.
- the polypeptides may be used for the treatment of diseases, including cancers that are sensitive to kynurenine depletion, with enzymes that deplete kynurenine, to prevent tumor-mediated tolerogenic effects and instead mediate tumor-ablating pro-inflammatory responses.
- kynureninases are contemplated for use in treating tumors expressing IDO1, IDO2, and/or TDO.
- modified polypeptide for treating diseases, such as tumors.
- the modified polypeptide may have human polypeptide sequences and thus may prevent allergic reactions in human patients, allow repeated dosing, and increase the therapeutic efficacy.
- Tumors for which the present treatment methods are useful include any malignant cell type, such as those found in a solid tumor or a hematological tumor.
- Exemplary solid tumors can include, but are not limited to, a tumor of an organ selected from the group consisting of pancreas, colon, cecum, stomach, brain, head, neck, ovary, kidney, larynx, sarcoma, lung, bladder, melanoma, prostate, and breast.
- Exemplary hematological tumors include tumors of the bone marrow, T or B cell malignancies, leukemias, lymphomas, blastomas, myelomas, and the like.
- cancers that may be treated using the methods provided herein include, but are not limited to, carcinoma, lymphoma, blastoma, sarcoma, leukemia, squamous cell cancer, lung cancer (including small-cell lung cancer, non-small cell lung cancer, adenocarcinoma of the lung, and squamous carcinoma of the lung), cancer of the peritoneum, hepatocellular cancer, gastric or stomach cancer (including gastrointestinal cancer and gastrointestinal stromal cancer), pancreatic cancer, glioblastoma, cervical cancer, ovarian cancer, liver cancer, bladder cancer, breast cancer, colon cancer, colorectal cancer, endometrial or uterine carcinoma, salivary gland carcinoma, kidney or renal cancer, prostate cancer, vulval cancer, thyroid cancer, various types of head and neck cancer, melanoma, superficial spreading melanoma, lentigo malignant melanoma, acral lentiginous melanomas, nodular melanomas, as well as B
- the cancer may specifically be of the following histological type, though it is not limited to these: neoplasm, malignant; carcinoma; carcinoma, undifferentiated; giant and spindle cell carcinoma; small cell carcinoma; papillary carcinoma; squamous cell carcinoma; lymphoepithelial carcinoma; basal cell carcinoma; pilomatrix carcinoma; transitional cell carcinoma; papillary transitional cell carcinoma; adenocarcinoma; gastrinoma, malignant; cholangiocarcinoma; hepatocellular carcinoma; combined hepatocellular carcinoma and cholangiocarcinoma; trabecular adenocarcinoma; adenoid cystic carcinoma; adenocarcinoma in adenomatous polyp; adenocarcinoma, familial polyposis coli; solid carcinoma; carcinoid tumor, malignant; branchiolo-alveolar adenocarcinoma; papillary adenocarcinoma; chromophobe carcinoma; acidophil carcinoma
- the kynureninase may be used herein as an antitumor agent in a variety of modalities for depleting kynurenine and/or 3'-hydroxy-kynurenine from tumor tissue, or the circulation of a mammal with cancer, or for depletion of kynurenine where its depletion is considered desirable.
- Depletion can be conducted in vivo in the circulation of a mammal, in vitro in cases where kynurenine and 3'-hydroxy-kynurenine depletion in tissue culture or other biological mediums is desired, and in ex vivo procedures where biological fluids, cells, or tissues are manipulated outside the body and subsequently returned to the body of the patient mammal.
- Depletion of kynurenine from circulation, culture media, biological fluids, or cells is conducted to reduce the amount of kynurenine accessible to the material being treated, and therefore comprises contacting the material to be depleted with a kynurenine-depleting amount of the kynureninase under kynurenine-depleting conditions as to degrade the ambient kynurenine in the material being contacted.
- treating a tumor cell includes contacting the nutrient medium for a population of tumor cells with the kynureninase.
- the medium may be blood, lymphatic fluid, spinal fluid and the like bodily fluid where kynurenine depletion is desired.
- Kynurenine- and 3'-hydroxy-kynurenine-depleting efficiency can vary widely depending upon the application, and typically depends upon the amount of kynurenine present in the material, the desired rate of depletion, and the tolerance of the material for exposure to kynureninase. Kynurenine and kynurenine metabolite levels in a material, and therefore rates of kynurenine and kynurenine metabolite depletion from the material, can readily be monitored by a variety of chemical and biochemical methods well known in the art.
- Exemplary kynurenine-depleting amounts are described further herein, and can range from 0.001 to 100 units (U) of kynureninase, preferably about 0.01 to 10 U, and more preferably about 0.1 to 5 U kyureninase per milliliter (mL) of material to be treated.
- Typical dosages can be administered based on body weight, and are in the range of about 5-1000 U/kilogram (kg)/day, preferably about 5-100 U/kg/day, more preferably about 10-50 U/kg/day, and more preferably about 20-40 U/kg/day.
- Kynurenine-depleting conditions are buffer and temperature conditions compatible with the biological activity of a kynureninase, and include moderate temperature, salt, and pH conditions compatible with the enzyme, for example, physiological conditions.
- Exemplary conditions include about 4-40 °C., ionic strength equivalent to about 0.05 to 0.2 M NaCl, and a pH of about 5 to 9, while physiological conditions are included.
- the invention contemplates methods of using a kynureninase as an antitumor agent, and therefore comprises contacting a population of tumor cells with a therapeutically effective amount of kynureninase for a time period sufficient to inhibit tumor cell growth.
- the contacting in vivo is accomplished by administering, by intravenous intraperitoneal, or intratumoral injection, a therapeutically effective amount of a physiologically tolerable composition comprising an kynureninase of this invention to a patient, thereby depleting the kynurenine source of the tumor cells present in the patient.
- a therapeutically effective amount of a kynureninase is a predetermined amount calculated to achieve the desired effect, i.e., to deplete kynurenine in the tumor tissue or in a patient's circulation, and thereby mediate a tumor-ablating pro-inflammatory response.
- the dosage ranges for the administration of kynureninase of the invention are those large enough to produce the desired effect in which the symptoms of tumor cell division and cell cycling are reduced.
- the dosage should not be so large as to cause adverse side effects, such as hyperviscosity syndromes, pulmonary edema, congestive heart failure, neurological effects, and the like.
- the dosage will vary with age of, condition of, sex of, and extent of the disease in the patient and can be determined by one of skill in the art. The dosage can be adjusted by the individual physician in the event of any complication.
- the kynureninase can be administered parenterally by injection or by gradual infusion over time.
- the kynureninase can be administered intravenously, intraperitoneally, orally, intramuscularly, subcutaneously, intracavity, transdermally, dermally, can be delivered by peristaltic means, can be injected directly into the tissue containing the tumor cells, or can be administered by a pump connected to a catheter that may contain a potential biosensor for kynurenine.
- the therapeutic compositions containing kynureninase are conventionally administered intravenously, as by injection of a unit dose, for example.
- unit dose when used in reference to a therapeutic composition refers to physically discrete units suitable as unitary dosage for the subject, each unit containing a predetermined quantity of active material calculated to produce the desired therapeutic effect in association with the required diluent, i.e., carrier, or vehicle.
- compositions are administered in a manner compatible with the dosage formulation, and in a therapeutically effective amount.
- quantity to be administered depends on the subject to be treated, capacity of the subject's system to utilize the active ingredient, and degree of therapeutic effect desired. Precise amounts of active ingredient required to be administered depend on the judgment of the practitioner and are peculiar to each individual. However, suitable dosage ranges for systemic application are disclosed herein and depend on the route of administration. Suitable regimes for initial administration and booster shots are also contemplated and are typified by an initial administration followed by repeated doses at one or more hour intervals by a subsequent injection or other administration.
- Exemplary multiple administrations are described herein and are particularly preferred to maintain continuously high serum and tissue levels of kynureninase and conversely low serum and tissue levels of kynurenine.
- continuous intravenous infusion sufficient to maintain concentrations in the blood in the ranges specified for in vivo therapies are contemplated.
- compositions and methods of the present invention involve modified kynureninases, such as by forming conjugates with heterologous peptide segments or polymers, such as polyethylene glycol.
- the kynureninases may be linked to PEG to increase the hydrodynamic radius of the enzyme and hence increase the serum persistence.
- the disclosed polypeptide may be conjugated to any targeting agent, such as a ligand having the ability to specifically and stably bind to an external receptor or binding site on a tumor cell ( U.S. Patent Publ. 2009/0304666 ).
- fusion proteins may have a native or modified kynureninase linked at the N- or C-terminus to a heterologous domain.
- fusions may also employ leader sequences from other species to permit the recombinant expression of a protein in a heterologous host.
- Another useful fusion includes the addition of a protein affinity tag, such as a serum albumin affinity tag or six histidine residues, or an immunologically active domain, such as an antibody epitope, preferably cleavable, to facilitate purification of the fusion protein.
- a protein affinity tag such as a serum albumin affinity tag or six histidine residues
- an immunologically active domain such as an antibody epitope, preferably cleavable
- Non-limiting affinity tags include polyhistidine, chitin binding protein (CBP), maltose binding protein (MBP), and glutathione-S-transferase (GST).
- the kynureninase may be linked to a peptide that increases the in vivo half-life, such as an XTEN polypeptide (Schellenberger et al., 2009), IgG Fc domain, albumin, or albumin binding peptide.
- a peptide that increases the in vivo half-life such as an XTEN polypeptide (Schellenberger et al., 2009), IgG Fc domain, albumin, or albumin binding peptide.
- fusion proteins are well known to those of skill in the art. Such proteins can be produced, for example, by de novo synthesis of the complete fusion protein, or by attachment of the DNA sequence encoding the heterologous domain, followed by expression of the intact fusion protein.
- Fusion proteins that recover the functional activities of the parent proteins may be facilitated by connecting genes with a bridging DNA segment encoding a peptide linker that is spliced between the polypeptides connected in tandem.
- the linker would be of sufficient length to allow proper folding of the resulting fusion protein.
- the kynureninase may be chemically conjugated using bifunctional cross-linking reagents or fused at the protein level with peptide linkers.
- Bifunctional cross-linking reagents have been extensively used for a variety of purposes, including preparation of affinity matrices, modification and stabilization of diverse structures, identification of ligand and receptor binding sites, and structural studies.
- Suitable peptide linkers may also be used to link the kynureninase, such as Gly-Ser linkers.
- Homobifunctional reagents that carry two identical functional groups proved to be highly efficient in inducing cross-linking between identical and different macromolecules or subunits of a macromolecule, and linking of polypeptide ligands to their specific binding sites.
- Heterobifunctional reagents contain two different functional groups. By taking advantage of the differential reactivities of the two different functional groups, cross-linking can be controlled both selectively and sequentially.
- the bifunctional cross-linking reagents can be divided according to the specificity of their functional groups, e.g. , amino-, sulfhydryl-, guanidine-, indole-, carboxyl-specific groups. Of these, reagents directed to free amino groups have become especially popular because of their commercial availability, ease of synthesis, and the mild reaction conditions under which they can be applied.
- heterobifunctional cross-linking reagents contain a primary amine-reactive group and a thiol-reactive group.
- heterobifunctional cross-linking reagents and methods of using the cross-linking reagents are described ( U.S. Pat. No. 5,889,155 , specifically incorporated herein by reference in its entirety).
- the cross-linking reagents combine a nucleophilic hydrazide residue with an electrophilic maleimide residue, allowing coupling, in one example, of aldehydes to free thiols.
- the cross-linking reagent can be modified to cross-link various functional groups.
- any other linking/coupling agents and/or mechanisms known to those of skill in the art may be used to combine kynureninase, such as, for example, antibody-antigen interaction, avidin biotin linkages, amide linkages, ester linkages, thioester linkages, ether linkages, thioether linkages, phosphoester linkages, phosphoramide linkages, anhydride linkages, disulfide linkages, ionic and hydrophobic interactions, bispecific antibodies and antibody fragments, or combinations thereof.
- kynureninase such as, for example, antibody-antigen interaction, avidin biotin linkages, amide linkages, ester linkages, thioester linkages, ether linkages, thioether linkages, phosphoester linkages, phosphoramide linkages, anhydride linkages, disulfide linkages, ionic and hydrophobic interactions, bispecific antibodies and antibody fragments, or combinations thereof.
- cross-linker having reasonable stability in blood will be employed.
- Numerous types of disulfide-bond containing linkers are known that can be successfully employed to conjugate targeting and therapeutic/preventative agents. Linkers that contain a disulfide bond that is sterically hindered may prove to give greater stability in vivo. These linkers are thus one group of linking agents.
- non-hindered linkers also can be employed in accordance herewith.
- Other useful cross-linkers include SATA, SPDP, and 2-iminothiolane (Wawrzynczak and Thorpe, 1987). The use of such cross-linkers is well understood in the art. Another embodiment involves the use of flexible linkers.
- the peptide generally will be purified to separate the conjugate from unconjugated agents and from other contaminants.
- a large number of purification techniques are available for use in providing conjugates of a sufficient degree of purity to render them clinically useful.
- Purification methods based upon size separation such as gel filtration, gel permeation, or high performance liquid chromatography, will generally be of most use. Other chromatographic techniques, such as Blue-Sepharose separation, may also be used. Conventional methods to purify the fusion proteins from inclusion bodies may be useful, such as using weak detergents, such as sodium N-lauroyl-sarcosine (SLS).
- weak detergents such as sodium N-lauroyl-sarcosine (SLS).
- kynureninase in certain aspects of the invention, methods and compositions related to PEGylation of kynureninase are disclosed.
- the kynureninase may be PEGylated in accordance with the methods disclosed herein.
- PEGylation is the process of covalent attachment of poly(ethylene glycol) polymer chains to another molecule, normally a drug or therapeutic protein. PEGylation is routinely achieved by incubation of a reactive derivative of PEG with the target macromolecule.
- the covalent attachment of PEG to a drug or therapeutic protein can "mask" the agent from the host's immune system (reduced immunogenicity and antigenicity) or increase the hydrodynamic size (size in solution) of the agent, which prolongs its circulatory time by reducing renal clearance.
- PEGylation can also provide water solubility to hydrophobic drugs and proteins.
- the first step of the PEGylation is the suitable functionalization of the PEG polymer at one or both terminals.
- PEGs that are activated at each terminus with the same reactive moiety are known as "homobifunctional,” whereas if the functional groups present are different, then the PEG derivative is referred as “heterobifunctional” or “heterofunctional.”
- the chemically active or activated derivatives of the PEG polymer are prepared to attach the PEG to the desired molecule.
- the choice of the suitable functional group for the PEG derivative is based on the type of available reactive group on the molecule that will be coupled to the PEG.
- typical reactive amino acids include lysine, cysteine, histidine, arginine, aspartic acid, glutamic acid, serine, threonine, and tyrosine.
- the N-terminal amino group and the C-terminal carboxylic acid can also be used.
- first generation PEG derivatives are generally reacting the PEG polymer with a group that is reactive with hydroxyl groups, typically anhydrides, acid chlorides, chloroformates, and carbonates.
- hydroxyl groups typically anhydrides, acid chlorides, chloroformates, and carbonates.
- more efficient functional groups such as aldehyde, esters, amides, etc., are made available for conjugation.
- heterobifunctional PEGs are very useful in linking two entities, where a hydrophilic, flexible, and biocompatible spacer is needed.
- Preferred end groups for heterobifunctional PEGs are maleimide, vinyl sulfones, pyridyl disulfide, amine, carboxylic acids, and NHS esters.
- the most common modification agents, or linkers, are based on methoxy PEG (mPEG) molecules. Their activity depends on adding a protein-modifying group to the alcohol end.
- PEG diol polyethylene glycol
- the diol is subsequently modified at both ends in order to make a hetero- or homo-dimeric PEG-linked molecule.
- Proteins are generally PEGylated at nucleophilic sites, such as unprotonated thiols (cysteinyl residues) or amino groups.
- cysteinyl-specific modification reagents include PEG maleimide, PEG iodoacetate, PEG thiols, and PEG vinylsulfone. All four are strongly cysteinyl-specific under mild conditions and neutral to slightly alkaline pH but each has some drawbacks.
- the thioether formed with the maleimides can be somewhat unstable under alkaline conditions so there may be some limitation to formulation options with this linker.
- the carbamothioate linkage formed with iodo PEGs is more stable, but free iodine can modify tyrosine residues under some conditions.
- PEG thiols form disulfide bonds with protein thiols, but this linkage can also be unstable under alkaline conditions.
- PEG-vinylsulfone reactivity is relatively slow compared to maleimide and iodo PEG; however, the thioether linkage formed is quite stable. Its slower reaction rate also can make the PEG-vinylsulfone reaction easier to control.
- cysteinyl residues Site-specific PEGylation at native cysteinyl residues is seldom carried out, since these residues are usually in the form of disulfide bonds or are required for biological activity.
- site-directed mutagenesis can be used to incorporate cysteinyl PEGylation sites for thiol-specific linkers.
- the cysteine mutation must be designed such that it is accessible to the PEGylation reagent and is still biologically active after PEGylation.
- Amine-specific modification agents include PEG NHS ester, PEG tresylate, PEG aldehyde, PEG isothiocyanate, and several others. All react under mild conditions and are very specific for amino groups.
- the PEG NHS ester is probably one of the more reactive agents; however, its high reactivity can make the PEGylation reaction difficult to control on a large scale.
- PEG aldehyde forms an imine with the amino group, which is then reduced to a secondary amine with sodium cyanoborohydride. Unlike sodium borohydride, sodium cyanoborohydride will not reduce disulfide bonds. However, this chemical is highly toxic and must be handled cautiously, particularly at lower pH where it becomes volatile.
- the reaction conditions may affect the stability of the protein. This may limit the temperature, protein concentration, and pH.
- the reactivity of the PEG linker should be known before starting the PEGylation reaction. For example, if the PEGylation agent is only 70 percent active, the amount of PEG used should ensure that only active PEG molecules are counted in the protein-to-PEG reaction stoichiometry.
- the present invention concerns novel compositions comprising at least one protein or peptide, such as a kynureninase.
- proteins or peptide such as a kynureninase.
- peptides may be comprised in a fusion protein or conjugated to an agent as described supra.
- a protein or peptide generally refers, but is not limited to, a protein of greater than about 200 amino acids, up to a full length sequence translated from a gene; a polypeptide of greater than about 100 amino acids; and/or a peptide of from about 3 to about 100 amino acids.
- a protein generally refers, but is not limited to, a protein of greater than about 200 amino acids, up to a full length sequence translated from a gene; a polypeptide of greater than about 100 amino acids; and/or a peptide of from about 3 to about 100 amino acids.
- protein protein
- polypeptide and “peptide” are used interchangeably herein.
- amino acid residue refers to any naturally occurring amino acid, any amino acid derivative, or any amino acid mimic known in the art.
- residues of the protein or peptide are sequential, without any non-amino acids interrupting the sequence of amino acid residues.
- sequence may comprise one or more non-amino acid moieties.
- sequence of residues of the protein or peptide may be interrupted by one or more non-amino acid moieties.
- protein or peptide encompasses amino acid sequences comprising at least one of the 20 common amino acids found in naturally occurring proteins, or at least one modified or unusual amino acid.
- Proteins or peptides may be made by any technique known to those of skill in the art, including the expression of proteins, polypeptides, or peptides through standard molecular biological techniques, the isolation of proteins or peptides from natural sources, or the chemical synthesis of proteins or peptides.
- the nucleotide and protein, polypeptide, and peptide sequences corresponding to various genes have been previously disclosed, and may be found at computerized databases known to those of ordinary skill in the art.
- One such database is the National Center for Biotechnology Information's Genbank and GenPept databases (available on the world wide web at ncbi.nlm.nih.gov/).
- the coding regions for known genes may be amplified and/or expressed using the techniques disclosed herein or as would be known to those of ordinary skill in the art. Alternatively, various commercial preparations of proteins, polypeptides, and peptides are known to those of skill in the art.
- nucleic acid sequences encoding a kynureninase or a fusion protein containing a kynureninase may be disclosed.
- nucleic acid sequences can be selected based on conventional methods. For example, if the kynureninase is derived from human kynureninase and contains multiple codons that are rarely utilized in E. coli, then that may interfere with expression. Therefore, the respective genes or variants thereof may be codon optimized for E. coli expression.
- Various vectors may be also used to express the protein of interest. Exemplary vectors include, but are not limited, plasmid vectors, viral vectors, transposon, or liposome-based vectors.
- Host cells may be any that may be transformed to allow the expression and secretion of kynureninase and conjugates thereof.
- the host cells may be bacteria, mammalian cells, yeast, or filamentous fungi.
- bacteria include Escherichia and Bacillus.
- Yeasts belonging to the genera Saccharomyces, Kiuyveromyces, Hansenula, or Pichia would find use as an appropriate host cell.
- Various species of filamentous fungi may be used as expression hosts, including the following genera: Aspergillus, Trichoderma, Neurospora, Penicillium, Cephalosporium, Achlya, Podospora, Endothia, Mucor, Cochliobolus, and Pyricularia.
- Examples of usable host organisms include bacteria, e.g., Escherichia coli MC1061, derivatives of Bacillus subtilis BRB1 (Sibakov et al., 1984), Staphylococcus aureus SAI123 (Lordanescu, 1975) or Streptococcus lividans (Hopwood et al., 1985); yeasts, e.g., Saccharomyces cerevisiae AH 22 (Mellor et al., 1983) or Schizosaccharomyces pombe; and filamentous fungi, e.g., Aspergillus nidulans, Aspergillus awamori (Ward, 1989), or Trichoderma reesei (Penttila et al., 1987; Harkki et al., 1989).
- bacteria e.g., Escherichia coli MC1061, derivatives of Bacillus subtilis BRB1 (Siba
- mammalian host cells examples include Chinese hamster ovary cells (CHO-K1; ATCC CCL61), rat pituitary cells (GH1; ATCC CCL82), HeLa S3 cells (ATCC CCL2.2), rat hepatoma cells (H-4-II-E; ATCCCRL 1548), SV40-transformed monkey kidney cells (COS-1; ATCC CRL 1650), and murine embryonic cells (NIH-3T3; ATCC CRL 1658).
- CHO-K1 Chinese hamster ovary cells
- GH1 rat pituitary cells
- ATCC CCL2.2 HeLa S3 cells
- H-4-II-E rat hepatoma cells
- COS-1 SV40-transformed monkey kidney cells
- NIH-3T3 ATCC CRL 1658
- Mammalian host cells expressing the kynureninase and/or their fusion proteins are cultured under conditions typically employed to culture the parental cell line. Generally, cells are cultured in a standard medium containing physiological salts and nutrients, such as standard RPMI, MEM, IMEM, or DMEM, typically supplemented with 5%-10% serum, such as fetal bovine serum. Culture conditions are also standard, e.g. , cultures are incubated at 37 °C in stationary or roller cultures until desired levels of the proteins are achieved.
- Protein purification techniques are well known to those of skill in the art. These techniques involve, at one level, the homogenization and crude fractionation of the cells, tissue, or organ to polypeptide and non-polypeptide fractions.
- the protein or polypeptide of interest may be further purified using chromatographic and electrophoretic techniques to achieve partial or complete purification (or purification to homogeneity) unless otherwise specified.
- Analytical methods particularly suited to the preparation of a pure peptide are ion-exchange chromatography, gel exclusion chromatography, polyacrylamide gel electrophoresis, affinity chromatography, immunoaffinity chromatography, and isoelectric focusing.
- a particularly efficient method of purifying peptides is fast-performance liquid chromatography (FPLC) or even high-performance liquid chromatography (HPLC).
- a purified protein or peptide is intended to refer to a composition, isolatable from other components, wherein the protein or peptide is purified to any degree relative to its naturally-obtainable state.
- An isolated or purified protein or peptide therefore, also refers to a protein or peptide free from the environment in which it may naturally occur.
- purified will refer to a protein or peptide composition that has been subjected to fractionation to remove various other components, and which composition substantially retains its expressed biological activity.
- substantially purified this designation will refer to a composition in which the protein or peptide forms the major component of the composition, such as constituting about 50%, about 60%, about 70%, about 80%, about 90%, about 95%, or more of the proteins in the composition.
- Various methods for quantifying the degree of purification of the protein or peptide are known to those of skill in the art in light of the present disclosure. These include, for example, determining the specific activity of an active fraction, or assessing the amount of polypeptides within a fraction by SDS/PAGE analysis.
- a preferred method for assessing the purity of a fraction is to calculate the specific activity of the fraction, to compare it to the specific activity of the initial extract, and to thus calculate the degree of purity therein, assessed by a "-fold purification number.”
- the actual units used to represent the amount of activity will, of course, be dependent upon the particular assay technique chosen to follow the purification, and whether or not the expressed protein or peptide exhibits a detectable activity.
- Partial purification may be accomplished by using fewer purification steps in combination, or by utilizing different forms of the same general purification scheme. For example, it is appreciated that a cation-exchange column chromatography performed utilizing an HPLC apparatus will generally result in a greater "-fold" purification than the same technique utilizing a low pressure chromatography system. Methods exhibiting a lower degree of relative purification may have advantages in total recovery of protein product, or in maintaining the activity of an expressed protein.
- a protein or peptide may be isolated or purified, for example, a kynureninase, a fusion protein containing a kynureninase, or a modified kynureninase post PEGylation.
- a His tag or an affinity epitope may be comprised in such a kynureninase to facilitate purification.
- Affinity chromatography is a chromatographic procedure that relies on the specific affinity between a substance to be isolated and a molecule to which it can specifically bind. This is a receptor-ligand type of interaction.
- the column material is synthesized by covalently coupling one of the binding partners to an insoluble matrix.
- the column material is then able to specifically adsorb the substance from the solution. Elution occurs by changing the conditions to those in which binding will not occur (e.g., altered pH, ionic strength, temperature, etc .).
- the matrix should be a substance that does not adsorb molecules to any significant extent and that has a broad range of chemical, physical, and thermal stability.
- the ligand should be coupled in such a way as to not affect its binding properties. The ligand should also provide relatively tight binding. It should be possible to elute the substance without destroying the sample or the ligand.
- Size exclusion chromatography is a chromatographic method in which molecules in solution are separated based on their size, or in more technical terms, their hydrodynamic volume. It is usually applied to large molecules or macromolecular complexes, such as proteins and industrial polymers.
- SEC Size exclusion chromatography
- the technique is known as gel filtration chromatography, versus the name gel permeation chromatography, which is used when an organic solvent is used as a mobile phase.
- SEC SEC-SEC
- particles of different sizes will elute (filter) through a stationary phase at different rates. This results in the separation of a solution of particles based on size. Provided that all the particles are loaded simultaneously or near simultaneously, particles of the same size should elute together.
- Each size exclusion column has a range of molecular weights that can be separated.
- the exclusion limit defines the molecular weight at the upper end of this range and is where molecules are too large to be trapped in the stationary phase.
- the permeation limit defines the molecular weight at the lower end of the range of separation and is where molecules of a small enough size can penetrate into the pores of the stationary phase completely and all molecules below this molecular mass are so small that they elute as a single band.
- High-performance liquid chromatography is a form of column chromatography used frequently in biochemistry and analytical chemistry to separate, identify, and quantify compounds.
- HPLC utilizes a column that holds chromatographic packing material (stationary phase), a pump that moves the mobile phase(s) through the column, and a detector that shows the retention times of the molecules. Retention time varies depending on the interactions between the stationary phase, the molecules being analyzed, and the solvent(s) used.
- novel kynureninase can be administered systemically or locally to inhibit tumor cell growth and, most preferably, to kill cancer cells in cancer patients with locally advanced or metastatic cancers. They can be administered intravenously, intrathecally, and/or intraperitoneally. They can be administered alone or in combination with anti-proliferative drugs. In one embodiment, they are administered to reduce the cancer load in the patient prior to surgery or other procedures. Alternatively, they can be administered after surgery to ensure that any remaining cancer (e.g ., cancer that the surgery failed to eliminate) does not survive.
- any remaining cancer e.g ., cancer that the surgery failed to eliminate
- compositions can be provided in formulations together with physiologically tolerable liquid, gel, or solid carriers, diluents, and excipients.
- physiologically tolerable liquid, gel, or solid carriers such as with domestic animals, and clinical use in humans in a manner similar to other therapeutic agents.
- these therapeutic preparations can be administered to mammals for veterinary use, such as with domestic animals, and clinical use in humans in a manner similar to other therapeutic agents.
- the dosage required for therapeutic efficacy will vary according to the type of use and mode of administration, as well as the particularized requirements of individual subjects.
- compositions are typically prepared as liquid solutions or suspensions, as injectables.
- Suitable diluents and excipients are, for example, water, saline, dextrose, glycerol, or the like, and combinations thereof.
- the compositions may contain minor amounts of auxiliary substances, such as wetting or emulsifying agents, stabilizing agents, or pH buffering agents.
- compositions comprising proteins, antibodies, and drugs in a form appropriate for the intended application.
- pharmaceutical compositions may comprise an effective amount of one or more kynureninase or additional agents dissolved or dispersed in a pharmaceutically acceptable carrier.
- pharmaceutically acceptable refers to molecular entities and compositions that do not produce an adverse, allergic, or other untoward reaction when administered to an animal, such as, for example, a human, as appropriate.
- compositions that contains at least one kyureninase isolated by the method disclosed herein, or additional active ingredient will be known to those of skill in the art in light of the present disclosure, as exemplified by Remington's Pharmaceutical Sciences, 18th Ed., 1990 , incorporated herein by reference. Moreover, for animal ( e.g ., human) administration, it will be understood that preparations should meet sterility, pyrogenicity, general safety, and purity standards as required by the FDA Office of Biological Standards.
- pharmaceutically acceptable carrier includes any and all solvents, dispersion media, coatings, surfactants, antioxidants, preservatives (e.g ., antibacterial agents, antifungal agents), isotonic agents, absorption delaying agents, salts, preservatives, drugs, drug stabilizers, gels, binders, excipients, disintegration agents, lubricants, sweetening agents, flavoring agents, dyes, such like materials and combinations thereof, as would be known to one of ordinary skill in the art (see, for example, Remington's Pharmaceutical Sciences, 18th Ed., 1990 , incorporated herein by reference). Except insofar as any conventional carrier is incompatible with the active ingredient, its use in the pharmaceutical compositions is contemplated.
- compositions of the present invention may comprise different types of carriers depending on whether it is to be administered in solid, liquid, or aerosol form, and whether it needs to be sterile for the route of administration, such as injection.
- the compositions can be administered intravenously, intradermally, transdermally, intrathecally, intraarterially, intraperitoneally, intranasally, intravaginally, intrarectally, intramuscularly, subcutaneously, mucosally, orally, topically, locally, by inhalation (e.g.
- lipid compositions e.g., liposomes
- aerosol inhalation by injection, by infusion, by continuous infusion, by localized perfusion bathing target cells directly, via a catheter, via a lavage, in lipid compositions ( e.g., liposomes), or by other methods or any combination of the forgoing as would be known to one of ordinary skill in the art (see, for example, Remington's Pharmaceutical Sciences, 18th Ed., 1990 , incorporated herein by reference).
- the modified polypeptides may be formulated into a composition in a free base, neutral, or salt form.
- Pharmaceutically acceptable salts include the acid addition salts, e.g., those formed with the free amino groups of a proteinaceous composition, or which are formed with inorganic acids, such as, for example, hydrochloric or phosphoric acids, or such organic acids as acetic, oxalic, tartaric, or mandelic acid.
- Salts formed with the free carboxyl groups can also be derived from inorganic bases, such as, for example, sodium, potassium, ammonium, calcium, or ferric hydroxides; or such organic bases as isopropylamine, trimethylamine, histidine, or procaine.
- solutions Upon formulation, solutions will be administered in a manner compatible with the dosage formulation and in such amount as is therapeutically effective.
- the formulations are easily administered in a variety of dosage forms, such as formulated for parenteral administrations, such as injectable solutions, or aerosols for delivery to the lungs, or formulated for alimentary administrations, such as drug release capsules and the like.
- the composition suitable for administration may be provided in a pharmaceutically acceptable carrier with or without an inert diluent.
- the carrier should be assimilable and includes liquid, semi-solid, i.e., pastes, or solid carriers. Except insofar as any conventional media, agent, diluent, or carrier is detrimental to the recipient or to the therapeutic effectiveness of a the composition contained therein, its use in administrable composition for use in practicing the methods is appropriate.
- carriers or diluents include fats, oils, water, saline solutions, lipids, liposomes, resins, binders, fillers, and the like, or combinations thereof.
- composition may also comprise various antioxidants to retard oxidation of one or more component. Additionally, the prevention of the action of microorganisms can be brought about by preservatives, such as various antibacterial and antifungal agents, including but not limited to parabens (e.g ., methylparabens, propylparabens), chlorobutanol, phenol, sorbic acid, thimerosal or combinations thereof.
- preservatives such as various antibacterial and antifungal agents, including but not limited to parabens (e.g ., methylparabens, propylparabens), chlorobutanol, phenol, sorbic acid, thimerosal or combinations thereof.
- the composition is combined with the carrier in any convenient and practical manner, i.e., by solution, suspension, emulsification, admixture, encapsulation, absorption, and the like. Such procedures are routine for those skilled in the art.
- the composition is combined or mixed thoroughly with a semi-solid or solid carrier.
- the mixing can be carried out in any convenient manner, such as grinding.
- Stabilizing agents can be also added in the mixing process in order to protect the composition from loss of therapeutic activity, i.e., denaturation in the stomach.
- stabilizers for use in a composition include buffers, amino acids, such as glycine and lysine, carbohydrates, such as dextrose, mannose, galactose, fructose, lactose, sucrose, maltose, sorbitol, mannitol, etc.
- the present invention may concern the use of a pharmaceutical lipid vehicle composition that includes kynureninases, one or more lipids, and an aqueous solvent.
- lipid will be defined to include any of a broad range of substances that is characteristically insoluble in water and extractable with an organic solvent. This broad class of compounds is well known to those of skill in the art, and as the term "lipid” is used herein, it is not limited to any particular structure. Examples include compounds that contain long-chain aliphatic hydrocarbons and their derivatives. A lipid may be naturally occurring or synthetic ( i.e., designed or produced by man). However, a lipid is usually a biological substance.
- Biological lipids are well known in the art, and include for example, neutral fats, phospholipids, phosphoglycerides, steroids, terpenes, lysolipids, glycosphingolipids, glycolipids, sulphatides, lipids with ether- and ester-linked fatty acids, polymerizable lipids, and combinations thereof.
- neutral fats phospholipids, phosphoglycerides, steroids, terpenes, lysolipids, glycosphingolipids, glycolipids, sulphatides, lipids with ether- and ester-linked fatty acids, polymerizable lipids, and combinations thereof.
- lipids are also encompassed by the compositions and methods.
- the kynureninase or a fusion protein thereof may be dispersed in a solution containing a lipid, dissolved with a lipid, emulsified with a lipid, mixed with a lipid, combined with a lipid, covalently bonded to a lipid, contained as a suspension in a lipid, contained or complexed with a micelle or liposome, or otherwise associated with a lipid or lipid structure by any means known to those of ordinary skill in the art.
- the dispersion may or may not result in the formation of liposomes.
- the actual dosage amount of a composition administered to an animal patient can be determined by physical and physiological factors, such as body weight, severity of condition, the type of disease being treated, previous or concurrent therapeutic interventions, idiopathy of the patient, and on the route of administration. Depending upon the dosage and the route of administration, the number of administrations of a preferred dosage and/or an effective amount may vary according to the response of the subject. The practitioner responsible for administration will, in any event, determine the concentration of active ingredient(s) in a composition and appropriate dose(s) for the individual subject.
- compositions may comprise, for example, at least about 0.1% of an active compound.
- an active compound may comprise between about 2% to about 75% of the weight of the unit, or between about 25% to about 60%, for example, and any range derivable therein.
- the amount of active compound(s) in each therapeutically useful composition may be prepared in such a way that a suitable dosage will be obtained in any given unit dose of the compound.
- Factors such as solubility, bioavailability, biological half-life, route of administration, product shelf life, as well as other pharmacological considerations, will be contemplated by one skilled in the art of preparing such pharmaceutical formulations, and as such, a variety of dosages and treatment regimens may be desirable.
- a dose may also comprise from about 1 microgram/kg/body weight, about 5 microgram/kg/body weight, about 10 microgram/kg/body weight, about 50 microgram/kg/body weight, about 100 microgram/kg/body weight, about 200 microgram/kg/body weight, about 350 microgram/kg/body weight, about 500 microgram/kg/body weight, about 1 milligram/kg/body weight, about 5 milligram/kg/body weight, about 10 milligram/kg/body weight, about 50 milligram/kg/body weight, about 100 milligram/kg/body weight, about 200 milligram/kg/body weight, about 350 milligram/kg/body weight, about 500 milligram/kg/body weight, to about 1000 milligram/kg/body weight or more per administration, and any range derivable therein.
- a range of about 5 milligram/kg/body weight to about 100 milligram/kg/body weight, about 5 microgram/kg/body weight to about 500 milligram/kg/body weight, etc. can be administered, based on the numbers described above.
- compositions and methods of the present embodiments involve administration of a kynureninase in combination with a second or additional therapy.
- a kynureninase in combination with a second or additional therapy.
- Such therapy can be applied in the treatment of any disease that is associated with kynurenine dependency.
- the disease may be cancer.
- the methods and compositions including combination therapies, enhance the therapeutic or protective effect, and/or increase the therapeutic effect of another anti-cancer or anti-hyperproliferative therapy.
- Therapeutic and prophylactic methods and compositions can be provided in a combined amount effective to achieve the desired effect, such as the killing of a cancer cell and/or the inhibition of cellular hyperproliferation.
- This process may involve administering a kynureninase and a second therapy.
- the second therapy may or may not have a direct cytotoxic effect.
- the second therapy may be an agent that upregulates the immune system without having a direct cytotoxic effect.
- a tissue, tumor, or cell can be exposed to one or more compositions or pharmacological formulation(s) comprising one or more of the agents (e.g., a kynureninase or an anti-cancer agent), or by exposing the tissue, tumor, and/or cell with two or more distinct compositions or formulations, wherein one composition provides 1) a kynureninase, 2) an anti-cancer agent, or 3) both a kynureninase and an anti-cancer agent.
- a combination therapy can be used in conjunction with chemotherapy, radiotherapy, surgical therapy, or immunotherapy.
- contacted and “exposed,” when applied to a cell are used herein to describe the process by which a therapeutic construct and a chemotherapeutic or radiotherapeutic agent are delivered to a target cell or are placed in direct juxtaposition with the target cell.
- both agents are delivered to a cell in a combined amount effective to kill the cell or prevent it from dividing.
- a kynureninase may be administered before, during, after, or in various combinations relative to an anti-cancer treatment.
- the administrations may be in intervals ranging from concurrently to minutes to days to weeks.
- the kynureninase is provided to a patient separately from an anti-cancer agent, one would generally ensure that a significant period of time did not expire between the time of each delivery, such that the two compounds would still be able to exert an advantageously combined effect on the patient.
- a course of treatment will last 1-90 days or more (this such range includes intervening days). It is contemplated that one agent may be given on any day of day 1 to day 90 (this such range includes intervening days) or any combination thereof, and another agent is given on any day of day 1 to day 90 (this such range includes intervening days) or any combination thereof. Within a single day (24-hour period), the patient may be given one or multiple administrations of the agent(s). Moreover, after a course of treatment, it is contemplated that there is a period of time at which no anti-cancer treatment is administered.
- This time period may last 1-7 days, and/or 1-5 weeks, and/or 1-12 months or more (this such range includes intervening days), depending on the condition of the patient, such as their prognosis, strength, health, etc. It is expected that the treatment cycles would be repeated as necessary.
- kynureninase is "A” and an anti-cancer therapy is "B":
- Administration of any compound or therapy of the present embodiments to a patient will follow general protocols for the administration of such compounds, taking into account the toxicity, if any, of the agents. Therefore, in some embodiments there is a step of monitoring toxicity that is attributable to combination therapy.
- chemotherapeutic agents may be used in accordance with the present embodiments.
- the term "chemotherapy” refers to the use of drugs to treat cancer.
- a "chemotherapeutic agent” is used to connote a compound or composition that is administered in the treatment of cancer. These agents or drugs are categorized by their mode of activity within a cell, for example, whether and at what stage they affect the cell cycle. Alternatively, an agent may be characterized based on its ability to directly cross-link DNA, to intercalate into DNA, or to induce chromosomal and mitotic aberrations by affecting nucleic acid synthesis.
- chemotherapeutic agents include alkylating agents, such as thiotepa and cyclosphosphamide; alkyl sulfonates, such as busulfan, improsulfan, and piposulfan; aziridines, such as benzodopa, carboquone, meturedopa, and uredopa; ethylenimines and methylamelamines, including altretamine, triethylenemelamine, trietylenephosphoramide, triethiylenethiophosphoramide, and trimethylolomelamine; acetogenins (especially bullatacin and bullatacinone); a camptothecin (including the synthetic analogue topotecan); bryostatin; callystatin; CC-1065 (including its adozelesin, carzelesin and bizelesin synthetic analogues); cryptophycins (particularly cryptophycin 1 and cryptophycin 8); dolastatin;
- paclitaxel and docetaxel gemcitabine 6-thioguanine; mercaptopurine; platinum coordination complexes, such as cisplatin, oxaliplatin, and carboplatin; vinblastine; platinum; etoposide (VP-16); ifosfamide; mitoxantrone; vincristine; vinorelbine; novantrone; teniposide; edatrexate; daunomycin; aminopterin; xeloda; ibandronate; irinotecan ( e.g ., CPT-11); topoisomerase inhibitor RFS 2000; difluorometlhylornithine (DMFO); retinoids, such as retinoic acid; capecitabine; carboplatin, procarbazine,plicomycin, gemcitabien, navelbine, farnesyl-protein tansferase inhibitors, transplatinum, and pharmaceutically acceptable salts,
- DNA damaging factors include what are commonly known as ⁇ -rays, X-rays, and/or the directed delivery of radioisotopes to tumor cells.
- Other forms of DNA damaging factors are also contemplated, such as microwaves, proton beam irradiation ( U.S. Patents 5,760,395 and 4,870,287 ), and UV-irradiation. It is most likely that all of these factors affect a broad range of damage on DNA, on the precursors of DNA, on the replication and repair of DNA, and on the assembly and maintenance of chromosomes.
- Dosage ranges for X-rays range from daily doses of 50 to 200 roentgens for prolonged periods of time (3 to 4 wk), to single doses of 2000 to 6000 roentgens.
- Dosage ranges for radioisotopes vary widely, and depend on the half-life of the isotope, the strength and type of radiation emitted, and the uptake by the neoplastic cells.
- immunotherapeutics generally, rely on the use of immune effector cells and molecules to target and destroy cancer cells.
- Rituximab (RITUXAN®) is such an example.
- Checkpoint inhibitors such as, for example, ipilumimab, are another such example.
- the immune effector may be, for example, an antibody specific for some marker on the surface of a tumor cell. The antibody alone may serve as an effector of therapy or it may recruit other cells to actually affect cell killing.
- the antibody also may be conjugated to a drug or toxin (chemotherapeutic, radionuclide, ricin A chain, cholera toxin, pertussis toxin, etc .) and serve merely as a targeting agent.
- the effector may be a lymphocyte carrying a surface molecule that interacts, either directly or indirectly, with a tumor cell target.
- Various effector cells include cytotoxic T cells and NK cells.
- the tumor cell must bear some marker that is amenable to targeting, i.e., is not present on the majority of other cells.
- Common tumor markers include CD20, carcinoembryonic antigen, tyrosinase (p97), gp68, TAG-72, HMFG, Sialyl Lewis Antigen, MucA, MucB, PLAP, laminin receptor, erb B, and p155.
- An alternative aspect of immunotherapy is to combine anticancer effects with immune stimulatory effects.
- Immune stimulating molecules also exist including: cytokines, such as IL-2, IL-4, IL-12, GM-CSF, gamma-IFN, chemokines, such as MIP-1, MCP-1, IL-8, and growth factors, such as FLT3 ligand.
- cytokines such as IL-2, IL-4, IL-12, GM-CSF, gamma-IFN
- chemokines such as MIP-1, MCP-1, IL-8
- growth factors such as FLT3 ligand.
- immunotherapies currently under investigation or in use are immune adjuvants, e.g., Mycobacterium bovis, Plasmodium falciparum, dinitrochlorobenzene, and aromatic compounds ( U.S. Patents 5,801,005 and 5,739,169 ; Hui and Hashimoto, 1998; Christodoulides et al., 1998); cytokine therapy, e.g., interferons ⁇ , ⁇ , and ⁇ , IL-1, GM-CSF, and TNF (Bukowski et al., 1998; Davidson et al., 1998; Hellstrand et al., 1998); gene therapy, e.g., TNF, IL-1, IL-2, and p53 (Qin et al., 1998; Austin-Ward and Villaseca, 1998; U.S.
- immune adjuvants e.g., Mycobacterium bovis, Plasmodium falciparum, dinitrochlorobenzene, and aromatic compounds
- Patents 5,830,880 and 5,846,945 ); and monoclonal antibodies, e.g. , anti-CD20, anti-ganglioside GM2, and anti-p185 (Hollander, 2012; Hanibuchi et al., 1998; U.S. Patent 5,824,311 ). It is contemplated that one or more anti-cancer therapies may be employed with the antibody therapies described herein.
- Curative surgery includes resection in which all or part of cancerous tissue is physically removed, excised, and/or destroyed and may be used in conjunction with other therapies, such as the treatment of the present embodiments, chemotherapy, radiotherapy, hormonal therapy, gene therapy, immunotherapy, and/or alternative therapies.
- Tumor resection refers to physical removal of at least part of a tumor.
- treatment by surgery includes laser surgery, cryosurgery, electrosurgery, and microscopically-controlled surgery (Mohs' surgery).
- a cavity may be formed in the body.
- Treatment may be accomplished by perfusion, direct injection, or local application of the area with an additional anti-cancer therapy. Such treatment may be repeated, for example, every 1, 2, 3, 4, 5, 6, or 7 days, or every 1, 2, 3, 4, and 5 weeks or every 1, 2, 3, 4, 5, 6, 7, 8, 9, 10, 11, or 12 months. These treatments may be of varying dosages as well.
- agents may be used in combination with certain aspects of the present embodiments to improve the therapeutic efficacy of treatment.
- additional agents include agents that affect the upregulation of cell surface receptors and GAP junctions, cytostatic and differentiation agents, inhibitors of cell adhesion, agents that increase the sensitivity of the hyperproliferative cells to apoptotic inducers, or other biological agents. Increases in intercellular signaling by elevating the number of GAP junctions would increase the anti-hyperproliferative effects on the neighboring hyperproliferative cell population.
- cytostatic or differentiation agents can be used in combination with certain aspects of the present embodiments to improve the anti-hyperproliferative efficacy of the treatments.
- Inhibitors of cell adhesion are contemplated to improve the efficacy of the present embodiments.
- Examples of cell adhesion inhibitors are focal adhesion kinase (FAKs) inhibitors and Lovastatin. It is further contemplated that other agents that increase the sensitivity of a hyperproliferative cell to apoptosis, such as the antibody c225, could be used in combination with certain aspects of the present embodiments to improve the treatment efficacy.
- kits such as therapeutic kits.
- a kit may comprise one or more pharmaceutical composition as described herein and optionally instructions for their use. Kits may also comprise one or more devices for accomplishing administration of such compositions.
- a subject kit may comprise a pharmaceutical composition and catheter for accomplishing direct intravenous injection of the composition into a cancerous tumor.
- a subject kit may comprise pre-filled ampoules of a kynureninase, optionally formulated as a pharmaceutical, or lyophilized, for use with a delivery device.
- Kits may comprise a container with a label.
- Suitable containers include, for example, bottles, vials, and test tubes.
- the containers may be formed from a variety of materials, such as glass or plastic.
- the container may hold a composition that includes a kynureninase that is effective for therapeutic or non-therapeutic applications, such as described above.
- the label on the container may indicate that the composition is used for a specific therapy or non-therapeutic application, and may also indicate directions for either in vivo or in vitro use, such as those described above.
- the kit of the invention will typically comprise the container described above and one or more other containers comprising materials desirable from a commercial and user standpoint, including buffers, diluents, filters, needles, syringes, and package inserts with instructions for use.
- Example 1 Gene construction, expression, and purification of kynureninase from Psuedomonas fluorescens
- a gene for expression of the kynureninase enzyme from Pseudomonas fluorescens was constructed by overlap extension polymerase chain reaction (PCR) of four codon optimized gene blocks designed using DNA-Works software (Hoover and Lubkowski, 2002).
- the full-length gene includes an N-terminal Xba I restriction enzyme site (nucleotides 1-6), an optimized ribosome binding site (RBS; nucleotides 29-55), a start codon (nucleotides 56-58), an N-terminal His 6 tag (nucleotides 59-91), an E.
- coli codon optimized Pf -KYNU gene (nucleotides 92-1336), a stop codon (nucleotides 1337-1342), and a C-terminal Bam HI restriction enzyme site (nucleotides 1342-1347) (see, SEQ ID NO: 1).
- the aforementioned restriction enzyme sites were used to clone the assembled gene into a pET-28a+ vector (Novagen). This construct was then used to transform BL21 (DE3) E. coli for expression. Cells were grown at 37 °C with shaking at 210 rpm in Terrific Broth (TB) media with 50 mg/L of kanamycin.
- the supernatant was then filtered through a 5 ⁇ m syringe filter and applied to a Ni-NTA/agarose column (Qiagen) pre-equilibrated in a buffer composed of 50 mM sodium phosphate, 300 mM NaCl, and 0.1 mM PLP at pH 7.4. After loading the lysate onto the column, the resin was washed with 5 column volumes (CV) of 50 mM sodium phosphate, pH 7.4, 300 mM NaCl, and 0.1 mM PLP with 30 mM imidazole.
- CV column volumes
- the flow rate was set to slowly wash the column overnight with 100 CV of endotoxin-free PBS (Corning) buffer with 0.1 mM PLP and 1% v/v TRITON® X114. This overnight wash removes lipopolysaccharide (LPS or endotoxin) that is a typical contaminant of bacterial expression systems.
- the washed enzyme was then eluted in 5 CV of endotoxin-free PBS with 0.1 mM PLP with 250 mM imidazole, and the resin was rinsed with a second 5 CV portion of endotoxin free PBS with 0.1 mM PLP.
- enzyme was buffer exchanged into fresh PBS to remove imidazole, 10% glycerol was added and aliquots were flash frozen in liquid nitrogen for storage at -80 °C.
- enzyme was immediately buffer exchanged into freshly made, sterile 100 mM sodium phosphate, pH 8.4, to both remove imidazole and prepare it for PEGylation (see, Example 4).
- Enzyme purities were typically >95% based on SDS-PAGE analysis and typical yields averaged around 75 mg/L of culture. Protein quantities were assessed by measuring Abs 280 nm and using the calculated enzyme extinction coefficient of 63,745 M -1 cm -1 .
- Example 2 Gene construction, expression, and purification of kynureninase from Homo sapiens
- a gene for expression of the kynureninase enzyme from Homo sapiens was obtained by overlap extension polymerase chain reaction (PCR) of four codon optimized gene blocks designed using DNA-Works software (Hoover and Lubkowski, 2002).
- the full-length gene includes an N-terminal Xba I restriction enzyme site (nucleotides 1-6), an optimized RBS (nucleotides 28-60), a start codon (nucleotides 61-63), an N-terminal His 6 tag (nucleotides 64-96), an E.
- coli codon optimized h -KYNU gene (nucleotides 97-1488), a stop codon (nucleotides 1489-1491), and a C-terminal Bam HI restriction enzyme site (nucleotides 1492-1497) (see, SEQ ID NO: 2).
- the aforementioned restriction enzyme sites were used to clone the assembled gene into a pET-28a+ vector (Novagen). This construct was then used to transform BL21 (DE3) E. coli for expression. Cells were grown at 37 °C with shaking at 210 rpm in Terrific Broth (TB) media with 50 mg/L of kanamycin.
- the supernatant was then filtered through a 5 ⁇ m syringe filter and applied to a Ni-NTA/agarose column (Qiagen) pre-equilibrated in 50 mM sodium phosphate, pH 7.4, 300 mM NaCl, and 0.1 mM PLP buffer. After loading the lysate onto the column, the resin was washed with 5 column volumes (CV) of 50 mM sodium phosphate, pH 7.4, 300 mM NaCl, and 0.1 mM PLP with 30 mM imidazole.
- CV column volumes
- the flow rate was set to slowly wash the column overnight with 100 CV of endotoxin-free PBS (Corning) buffer with 0.1 mM PLP and 1% v/v TRITON® X114. This overnight wash removes lipopolysaccharide (LPS or endotoxin) that is a typical contaminant in bacterial expression of enzymes.
- the washed enzyme was then eluted in 5 CV of endotoxin free PBS with 0.1 mM PLP with 250 mM imidazole and the resin was rinsed with a second 5 CV portions of endotoxin free PBS with 0.1 mM PLP.
- enzyme was buffer exchanged into fresh PBS to remove imidazole, 10% glycerol was added and aliquots were flash frozen in liquid nitrogen for storage at -80 °C.
- enzyme could be buffer exchanged into freshly made, sterile 100 mM sodium phosphate, pH 8.4, to both remove imidazole and prepare it for PEGylation (see, Example 4).
- Enzyme purities were typically >95% as assessed by SDS-PAGE analysis and typical yields averaged around 20 mg/L of liquid culture. Protein quantities were assessed by measuring Abs 280 nm and using the calculated enzyme extinction coefficient of 76,040 M -1 cm -1 .
- Example 3 Gene construction, expression, and purification of kynureninase from Mus musculus
- a gene for expression of the kynureninase enzyme from Mus musculus was obtained by overlap extension polymerase chain reaction (PCR) of three codon optimized gene blocks designed using DNA-Works software (Hoover et al., 2002).
- the full-length gene included an N-terminal Xba I restriction enzyme site (nucleotides 1-6), an optimized RBS (nucleotides 29-58), a start codon (nucleotides 59-61), an N-terminal His 6 tag (nucleotides 62-94), an E.
- coli codon optimized m -KYNU gene (nucleotides 95-1483), a stop codon (nucleotides 1484-1486), and a C-terminal Bam HI restriction enzyme site (nucleotides 1487-1492) (see, SEQ ID NO: 3).
- the aforementioned restriction enzyme sites were used to clone the assembled gene into a pET-28a+ vector (Novagen). This construct was then used to transform BL21 (DE3) E. coli for expression. Cells were grown at 37 °C shaking at 210 rpm in Terrific Broth (TB) media with 50 mg/L of kanamycin.
- the supernatant was filtered through a 5 ⁇ m syringe filter and applied to a Ni-NTA/agarose column (Qiagen) pre-equilibrated in 50 mM sodium phosphate, pH 7.4, 300 mM NaCl, and 0.1 mM PLP buffer. After loading the lysate onto the column, the resin was washed with 5 column volumes (CV) of 50 mM sodium phosphate, pH 7.4, 300 mM NaCl, and 0.1 mM PLP with 30 mM imidazole. Next the flow rate was set to slowly wash overnight with 100 CV of endotoxin-free PBS (Corning) buffer with 0.1 mM PLP and 1% v/v TRITON® X114.
- CV column volumes
- This overnight wash removeD lipopolysaccharide (LPS or endotoxin) that is a typical contaminant in bacterial expression of enzymes.
- the washed enzyme was eluted in 5 CV of endotoxin-free PBS with 0.1 mM PLP with 250 mM imidazole and the resin rinsed with a second 5 CV portion of endotoxin-free PBS with 0.1 mM PLP.
- enzyme was buffer exchanged into fresh PBS to remove imidazole, 10% glycerol added and aliquots flash frozen in liquid nitrogen for storage at -80 °C.
- the hydrodynamic radius of KYNU enzymes was increased by functionalizing surface reactive groups in the protein by conjugation to PEG.
- Pf -KYNU was functionalized by reaction of surface lysine residues with Methoxyl PEG Succinimidyl Carbonate 5000 MW (NANOCS).
- NANOCS Methoxyl PEG Succinimidyl Carbonate 5000 MW
- Un-reacted PEG was removed from solution by thorough buffer exchange into fresh, endotoxin-free PBS in a 100 kDa cut off centrifugal filtration device (AMICON®).
- the apparent molecular mass of the enzyme was then checked on a size exclusion HPLC column (Phenomenex) in PBS.
- a MW standard solution from BioRad was used to generate a standard curve and enzyme retention times compared to those of the protein standards. Based on the standard curve, the non-PEGylated enzyme has an apparent mass of 40 kDa, which is close to that of the mass of one monomer of Pf -KYNU.
- the PEGylated version of the enzyme was seen to have an apparent mass of 1,300 kDa, i.e.
- Endotoxin levels were quantified using the Chromo-LAL kinetic chromogenic endotoxin testing kit (Associates of Cape Cod, Inc.). Enzyme washed in the manner described above typically resulted in endotoxin levels 0.19 ⁇ 0.07 EU/mg of purified Pf -KYNU.
- h -KYNU was functionalized by reaction of surface lysine residues with Methoxyl PEG Succinimidyl Carbonate 5000 MW (NANOCS).
- NANOCS Methoxyl PEG Succinimidyl Carbonate 5000 MW
- Un-reacted PEG was removed from solution by thorough buffer exchange into fresh, endotoxin-free PBS in a 100 kDa cut off centrifugal filtration device (AMICON®).
- AMICON® 100 kDa cut off centrifugal filtration device
- the apparent molecular mass of the enzyme was determined using a size exclusion HPLC column (Phenomenex) equilibrated with PBS and retention times compared to a MW standard solution (BioRad). Endotoxin levels were quantified using the Chromo-LAL kinetic chromogenic endotoxin testing kit (Associates of Cape Cod, Inc.).
- Example 6 Assay for measuring kinetic parameters of kynureninase
- L-kynurenine solutions were prepared in a PBS buffer, pH 7.4, to result in final concentrations ranging from 8 ⁇ M to 250 ⁇ M.
- L-Kynurenine has an extinction coefficient of 4,500 M -1 cm -1 with a ⁇ max at 365 nm while the products of the kynureninase reaction, L-anthranilic acid and L-alanine, do not appreciably absorb at 365 nm.
- Reactions were initiated by adding and rapidly mixing enzyme solutions ( ⁇ 20 nM final) with the substrate solutions and monitoring the loss of substrate KYN at 25 °C by measuring Abs 365 nm over time. The resulting data was processed and fitted to the Michaelis-Menten equation for determining kinetic constants. The kinetics of PEGylated Pf -KYNU enzyme was measured in an identical manner.
- k cat / K M 1.0 ⁇ 10 5 M -1 s -1
- k cat / K M 1.3 ⁇ 10 5 M -1 s -1
- Kinetic parameters for the hydrolysis of 3-hydroxy-L-kynurenic acid were also determined as described here.
- Example 8 Assay for quantifying kynurenine and tryptophan levels in vivo
- the growth rates of B16 melanoma tumors was significantly retarded in the treatment group administered active PEG- Pf -KYNU compared to the identically treated heat-inactivated PEG- Pf -KYNU group ( FIG. 3 ) resulting in a significant life-span extension ( FIG. 4 ).
- Lymphocytes isolated from control and experimental treatment groups were assessed with panels of antibodies (i.e., anti-CD45, CD4, Nk1.1, CD25, FoxP3, CD8, granzyme B, IFN ⁇ , CTLA4, CD11c, CD11b, F4/80, GR-1, and Ly6-C) which revealed that the population of circulating CD4+ CD25+ FoxP3+ regulatory T-cells was significantly lower in the group treated with active PEG- Pf -KYNU (4.8 ⁇ 0.8% vs . 8.6 ⁇ 0.8%).
- the population of tumor infiltrating CD8+ T-cells expressing granzyme B and interferon ⁇ was significantly higher in mice treated with active enzyme (26 ⁇ 19% vs . 4 ⁇ 2%) ( FIGs. 5A-B ).
- the present invention also contemplates polypeptides comprising the modified bacterial or mammalian kynureninase linked to a heterologous amino acid sequence.
- the native or modified kynureninase may be linked to a single-chain variable fragment (scFv) antibody that binds specific cell surface tumor antigens.
- scFv single-chain variable fragment
- an scFv-kynureninase fusion protein with the scFv portion of the protein having specific affinity for a known tumor antigen, preferably a tumor specific antigen that internalizes at a slower rate, e.g., MUC-1, would allow the kynureninase portion of the fusion protein to be delivered to the tumor cell and degrade KYN.
- a tumor specific antigen that internalizes at a slower rate e.g., MUC-1
- One example would be a scFv-kynureninase fusion protein where the scFv portion targets and binds to the human epidermal growth factor receptor 2 (HER2) that is upregulated in certain types of breast cancer.
- HER2 human epidermal growth factor receptor 2
- a native or modified kynureninase-anti-HER2-scFV fusion protein would act to target and concentrate kynureninase directly to the tumor surface and act to degrade tumor-produced KYN.
- the present invention also contemplates polypeptides comprising the modified bacterial or mammalian kynureninase linked to a heterologous amino acid sequence.
- the native or modified kynureninase may be linked to a single-chain variable fragment (scFv) antibody that binds the Cytotoxic T-Lymphocyte Antigen 4 (CTLA-4) receptor, Programmed Cell Death 1 (PD-1), or Programmed Cell Death Ligand 1 (PD-L1).
- CTLA-4, PD-1, or PD-L1 A blockade of CTLA-4, PD-1, or PD-L1 by an antagonizing antibody or antibody fragment allows the inhibitory T-cell signal to be reversed allowing CD28 to stimulate T-cell activation.
- a native or modified kynureninase-anti-CTLA4-, anti-PD-1-, or anti-PD-Ll-scFv fusion protein would act to remove both inhibitory protein:protein interaction signaling and inhibitory kynurenine signaling.
- This embodiment of a native or modified kynureninase-scFv fusion protein would be expected to potently upregulate T-cell activation and promote robust anti-tumoral responses.
- Example 12 Chimeric antigen receptor constructs for delivery of kynureninase to T cells
- the present invention also contemplates a lentiviral vector suitable for transfection of T cells with chimeric antigen receptor (CAR) constructs such that a modified bacterial or mammalian kynureninase would be co-expressed in addition to the CAR construct.
- CAR constructs are proteins containing an extracellular antigen binding domain fused to a transmembrane and cytoplasmic signaling domain from a CD3- ⁇ chain and often a CD28 molecule (Ahmed et al., 2010).
- the antigen binding domain may be an scFv designed to bind an antigen expressed by a tumor cell with examples being HER2 expressed by glioblastoma or osteosarcoma, CD19 or CD20 expressed by various B-cell malignancies, or GD2 expressed by neuroblastoma (Lipowska-Bhalla et al., 2012) or any other relevant target.
- the lentiviral vector delivering an appropriate CAR construct to a T cell, would in addition co-express a native or modified bacterial or mammalian kynureninase in the cytosol.
- the T cell containing this CAR/kynureninase construct would have the dual ability to 1) bind to specific tumor cells and 2) to degrade KYN, preventing KYN induction of a regulatory phenotype and or apoptosis.
- a T cell would express a CAR construct that binds a CD19+ or CD20+ diffuse large B-cell lymphoma while co-expressing a kynureninase to degrade the high concentrations of KYN often produced by this tumor type (Yoshikawa et al., 2010; de Jong et al., 2011; Yao et al., 2011).
- the amino acid L-tryptophan (L-Trp) is synthesized from the pentose derived precursor, chorismate, by expression of the trp biosynthetic genes.
- the trp biosynthetic genes are organized in an operon composed of five genes; trpE, trpD, trpC, trpB, and trpA.
- the TrpE and TrpD proteins are components of the anthranilate synthase complex that catalyzes the first step in the conversion of chorismate and L-glutamine to anthranilic acid and L-glutamate.
- Anthranilic acid is then subsequently converted to L-Trp by the action of TrpC, TrpA, and TrpB.
- Cells lacking a functional anthranilate synthase gene are auxotrophic for L-Trp and cannot grow in minimal media without tryptophan.
- cells that do not express the enzyme or express variants with low catalytic activity should display either no growth or very slow growth, respectively, on minimal media with L-kynurenine.
- E. coli trpE and trpD deletion mutants were obtained from Genetic Resources at Yale CGSC.
- Strain genotypes were (F-, ⁇ (araD-araB)567, ⁇ lacZ4787(::rrnB-3), ⁇ -, ⁇ trpE772::kan, rph-1, ⁇ (rhaD-rhaB)568, hsdR514) and (F-, ⁇ (araD-araB)567, ⁇ lacZ4787(::rrnB-3), ⁇ -, ⁇ trpD771::kan, rph-1, ⁇ (rhaD-rhaB)568, hsdR514), respectively.
- E. coli- ⁇ trpD cells only grew in the presence of L-Trp, however E. coli- ⁇ trpE could also grow in the presence of anthranilic acid but not buffer or L-Kyn, demonstrating that trpC, trpA, and trpB were expressed, allowing rescue of the L-Trp auxotrophy with anthranilic acid as an intermediate metabolite ( FIG. 6 ). Furthermore, E. coli- ⁇ trpE cells transformed with a plasmid harboring the Pf -KYNU gene grew robustly on M9 minimal media plates in the presence of L-Kyn.
- Example 14 Gene construction, expression and purification of bacterial kynureninases displaying high catalytic activity towards kynurenine and identity to the human kynureninase
- the Homo sapiens enzyme is highly selective towards the hydrolysis of 3'-OH kynurenine and has about 1,000-fold lower catalytic activity towards kynurenine. Because of its poor catalytic activity towards kynurenine, the human enzyme is not suitable for therapeutic purposes.
- Administration of PEGylated Pf -KYNU (Example 9), Mu -KYNU (Example 22 and Example 23), or Cp -KYNU (Example 17) all of which display high catalytic activity towards kynurenine instead of 3'-OH kynurenine
- Example 9 FIG. 3
- the Pf -KYNU displays low sequence identity to its human counterpart (24% amino acid identity). Due to its low sequence identity to the human protein, Pf -KYNU may elicit adverse immune responses in patients as well as the production of neutralizing antibodies. Therefore it is important to discover kynureninase enzymes that display high catalytic activity and selectivity towards kynurenine and have a higher degree of amino acid identity to the Homo sapiens kynureninase. The inventors identified a number of bacterial enzymes that display >38% amino acid identity to the Homo sapiens kynureninase and also high kynurenine hydrolysis activity. The sequences of these enzymes are provided as SEQ ID NOs: 13-52.
- kynureninase The percent identities of these enzymes as compared to Homo sapiens kynureninase are provided in Table 1.
- a gene for expression of the kynureninase enzyme from Mucilaginibacter paludis ( Mu -KYNU) (SEQ ID NO: 33) was constructed by overlap extension polymerase chain reaction (PCR) of two codon optimized gene blocks designed using the DNA-Works software (Hoover and Lubkowski, 2002).
- the full-length gene includes an N-terminal NcoI restriction enzyme site, an optimized RBS, an N-terminal His 6 tag, E. coli codon optimized Mu -KYNU gene, a stop codon and a C-terminal Eco RI restriction enzyme site.
- lysis buffer consisting of 50 mM sodium phosphate, pH 7.4, 300 mM NaCl, 0.5 mM pyridoxyl phosphate (PLP), 1 mM phenylmethylsulfonylfluoride, and 1 ⁇ g/mL DNase. Lysis was achieved by French press and the lysate was cleared of particulates by centrifuging at 20,000 x g for 1 h at 4 °C.
- the supernatant was then filtered through a 5 ⁇ m syringe filter and applied to a Ni-NTA/agarose column (Qiagen) pre-equilibrated in 50 mM sodium phosphate, pH 7.4, 300 mM NaCl, and 0.1 mM PLP buffer. After loading the lysate onto the column, the resin was washed with 5 column volumes (CV) of 50 mM sodium phosphate, pH 7.4, 300 mM NaCl, and 0.1 mM PLP with 30 mM imidazole. The washed enzyme was then eluted in 5 CV of PBS with 0.1 mM PLP with 250 mM imidazole.
- CV column volumes
- enzyme was buffer exchanged into fresh PBS to remove imidazole, 10% glycerol was added and aliquots were flash frozen in liquid nitrogen for storage at -80 °C.
- Enzyme purities were typically >95% based on SDS-PAGE analysis and typical yields averaged around 75 mg/L of culture. Protein quantities were assessed by measuring Abs 280 nm and using the calculated enzyme extinction coefficient of 78,185 M -1 cm -1 . Table 1. Percent identities of eubacterial kynureninase enzymes as compared to Homo sapiens kynureninase.
- the kinetic parameters of Mu -KYNU were quantified by a spectrophotometric assay, in which the decay in the maximum absorbance of the enzyme substrate, L-kynurenine, was monitored as a function of time.
- L-Kynurenine solutions were prepared in a PBS buffer, pH 7.4, to result in final concentrations ranging from 16 ⁇ M to 500 ⁇ M.
- L-Kynurenine has an extinction coefficient of 4,500 M -1 cm -1 with a ⁇ max at 365 nm while the products of the kynureninase reaction, L-anthranilic acid and L-alanine, do not appreciably absorb at 365 nm.
- Example 17 Gene construction, expression, and purification of kynureninase from Chlamydophila pecorum
- a gene for expression of the kynureninase enzyme from Chlamydophila pecorum was synthesized using E. coli -codon optimized gene blocks.
- the full-length gene includes an N-terminal Nco I restriction enzyme site (nucleotides 1-6), a start codon (nucleotides 3-5), an N-terminal His 6 tag (nucleotides 6-35), an E. coli codon optimized Cp -KYNU gene (nucleotides 36-1295), a stop codon (nucleotides 1296-1298), and a C-terminal Eco RI restriction enzyme site (nucleotides 1299-1304) (SEQ ID NO: 53).
- lysis buffer consisting of 50 mM sodium phosphate, pH 7.4, 300 mM NaCl, 0.5 mM pyridoxyl phosphate (PLP), 1 mM phenylmethylsulfonylfluoride, and 1 ⁇ g/mL DNase. Lysis was achieved by French press and the lysate was cleared of particulates by centrifuging at 20,000 x g for 1 h at 4 °C.
- the supernatant was then filtered through a 5 ⁇ m syringe filter and applied to a Ni-NTA/agarose column (Qiagen) pre-equilibrated in 50 mM sodium phosphate, pH 7.4, 300 mM NaCl, and 0.1 mM PLP buffer.
- the resin was washed with 10 column volumes (CV) of 50 mM sodium phosphate, pH 7.4, 300 mM NaCl, and 0.1 mM PLP with 30 mM imidazole.
- the washed enzyme was then eluted with 5 CV of PBS containing 0.1 mM PLP and 250 mM imidazole.
- the eluted enzyme was buffer exchanged into fresh PBS to remove imidazole, 10% glycerol was added, and aliquots were flash frozen in liquid nitrogen for storage at -80 °C.
- Cp -KYNU SEQ ID NO: 57
- the kinetic parameters of Cp -KYNU were quantified by a spectrophotometric assay, in which the decay in the maximum absorbance of the enzyme substrate, L-kynurenine, was monitored as a function of time.
- L-Kynurenine solutions were prepared in PBS buffer, pH 7.4, to result in final concentrations ranging from 16 ⁇ M to 500 ⁇ M.
- L-Kynurenine has an extinction coefficient of 4,500 M -1 cm -1 with a ⁇ max at 365 nm while the products of the kynureninase reaction, anthranilate and L-alanine, do not appreciably absorb at 365 nm.
- Example 19 Pharmacological preparation of kynureninase from Mucilaginibacter paludis
- Mu -KYNU was PEGylated by reaction of surface lysine residues with Methoxyl PEG Succinimidyl Carbonate 5000 MW (NANOCS).
- NANOCS Methoxyl PEG Succinimidyl Carbonate 5000 MW
- the purified Mu -KYNU was determined to contain very low endotoxin levels ( ⁇ 20 EU/mg) as described below. It was thoroughly buffer exchanged into freshly prepared 100 mM sodium phosphate buffer, pH 8.4, and concentrated to greater than 1 mg/mL.
- the resultant solution was added directly to a 100:1 molar excess of solid PEG reagent and allowed to react at room temperature for 1 h with stirring. Un-reacted PEG was removed from solution by thorough buffer exchange into fresh, endotoxin-free PBS in a 100 kDa cutoff centrifugal filtration device (Amicon). The apparent molecular mass of the enzyme was then checked on a size exclusion HPLC column (Phenomenex) in PBS using a MW standard solution from BioRad to generate a standard curve, and enzyme retention times were compared to those of the protein standards. Endotoxin levels were quantified using the Chromo-LAL kinetic chromogenic endotoxin testing kit (Associates of Cape Cod, Inc.).
- Example 20 Enhanced L-kynurenine degradation in an engineered human kynureninase variant
- the h -KYNU enzyme is highly selective towards the hydrolysis of 3'-OH kynurenine and has about 1,000 fold lower catalytic activity towards L-kynurenine. Because of its poor catalytic activity towards L-kynurenine, the wild-type human enzyme is not suitable for therapeutic purposes.
- a saturation mutagenesis library was constructed by overlap extension polymerase chain reaction (PCR) using the h -KYNU gene and a pair of oligonucleotides designed to introduce mutations of the codon corresponding to amino acid F306.
- F306 is located within the active site of h -KYNU where it appears to play a role in substrate binding.
- the F306 saturation library was screened for activity using the microtiter plate kynureninase assay of Example 6. More than a dozen clones displayed significantly higher activity than wild-type h -KYNU and were selected for further analysis. Sequencing of these clones revealed that two amino acid substitutions at position F306 resulted in increased L-kynurenine degrading activity, namely h -KYNU-F306M (SEQ ID NO: 55) and h -KYNU-F306L (SEQ ID NO: 56).
- Example 21 Comparison of Pf -KYNU, anti-PDl, and anti-CTLA-4 therapies in the autologous B16 mouse melanoma model
- PEGylated enzymes (PEG- Pf -KYNU and PEG- Mu -KYNU) were evaluated in B16 melanoma allografts in combination with the anti-PDl immune checkpoint inhibitor antibody (Curran et al., 2010).
- mice were treated with 250 ⁇ g anti-PDl by IP injection (clone RMP1-14, BioXCell # BE0146) on days 10, 13, and 16 either with or without 500 ⁇ g PEG- Pf -KYNU or 500 ⁇ g PEG- Mu -KYNU s.c. near the tumor site.
- Mice received a total of six doses of KYNU between days 10 and 25.
- One group was given PBS injections i.p. as a control for PD-1. Tumor growth was drastically impaired or even reversed in all treatment arms compared to PBS control ( FIG. 9A ).
- the present invention further provides the following items 1 to 74:
Landscapes
- Health & Medical Sciences (AREA)
- Life Sciences & Earth Sciences (AREA)
- Chemical & Material Sciences (AREA)
- Engineering & Computer Science (AREA)
- Organic Chemistry (AREA)
- Genetics & Genomics (AREA)
- Bioinformatics & Cheminformatics (AREA)
- General Health & Medical Sciences (AREA)
- Zoology (AREA)
- Wood Science & Technology (AREA)
- Medicinal Chemistry (AREA)
- Biomedical Technology (AREA)
- General Engineering & Computer Science (AREA)
- Biotechnology (AREA)
- Biochemistry (AREA)
- Animal Behavior & Ethology (AREA)
- Veterinary Medicine (AREA)
- Public Health (AREA)
- Pharmacology & Pharmacy (AREA)
- Immunology (AREA)
- Molecular Biology (AREA)
- Microbiology (AREA)
- Epidemiology (AREA)
- Cell Biology (AREA)
- General Chemical & Material Sciences (AREA)
- Nuclear Medicine, Radiotherapy & Molecular Imaging (AREA)
- Chemical Kinetics & Catalysis (AREA)
- Hematology (AREA)
- Developmental Biology & Embryology (AREA)
- Virology (AREA)
- Proteomics, Peptides & Aminoacids (AREA)
- Gastroenterology & Hepatology (AREA)
- Physics & Mathematics (AREA)
- Plant Pathology (AREA)
- Biophysics (AREA)
- Medicines That Contain Protein Lipid Enzymes And Other Medicines (AREA)
- Enzymes And Modification Thereof (AREA)
- Medicinal Preparation (AREA)
- Medicines Containing Material From Animals Or Micro-Organisms (AREA)
- Medicines Containing Antibodies Or Antigens For Use As Internal Diagnostic Agents (AREA)
Applications Claiming Priority (4)
| Application Number | Priority Date | Filing Date | Title |
|---|---|---|---|
| US201361872132P | 2013-08-30 | 2013-08-30 | |
| US201461986366P | 2014-04-30 | 2014-04-30 | |
| EP14840339.7A EP3038636B1 (en) | 2013-08-30 | 2014-08-29 | Administration of kynurenine depleting enzymes for tumor therapy |
| PCT/US2014/053437 WO2015031771A2 (en) | 2013-08-30 | 2014-08-29 | Administration of kynurenine depleting enzymes for tumor therapy |
Related Parent Applications (1)
| Application Number | Title | Priority Date | Filing Date |
|---|---|---|---|
| EP14840339.7A Division EP3038636B1 (en) | 2013-08-30 | 2014-08-29 | Administration of kynurenine depleting enzymes for tumor therapy |
Publications (1)
| Publication Number | Publication Date |
|---|---|
| EP3492094A1 true EP3492094A1 (en) | 2019-06-05 |
Family
ID=52583559
Family Applications (2)
| Application Number | Title | Priority Date | Filing Date |
|---|---|---|---|
| EP18204264.8A Withdrawn EP3492094A1 (en) | 2013-08-30 | 2014-08-29 | Administration of kynurenine depleting enzymes for tumor therapy |
| EP14840339.7A Active EP3038636B1 (en) | 2013-08-30 | 2014-08-29 | Administration of kynurenine depleting enzymes for tumor therapy |
Family Applications After (1)
| Application Number | Title | Priority Date | Filing Date |
|---|---|---|---|
| EP14840339.7A Active EP3038636B1 (en) | 2013-08-30 | 2014-08-29 | Administration of kynurenine depleting enzymes for tumor therapy |
Country Status (12)
| Country | Link |
|---|---|
| US (5) | US9808486B2 (enExample) |
| EP (2) | EP3492094A1 (enExample) |
| JP (4) | JP6307163B2 (enExample) |
| KR (2) | KR102271498B1 (enExample) |
| CN (2) | CN113957061A (enExample) |
| AU (1) | AU2014312119B2 (enExample) |
| BR (1) | BR112016004095A2 (enExample) |
| CA (2) | CA3173052A1 (enExample) |
| ES (1) | ES2707711T3 (enExample) |
| IL (2) | IL244312B (enExample) |
| WO (1) | WO2015031771A2 (enExample) |
| ZA (1) | ZA201601443B (enExample) |
Families Citing this family (23)
| Publication number | Priority date | Publication date | Assignee | Title |
|---|---|---|---|---|
| EP4282419A1 (en) | 2012-12-20 | 2023-11-29 | Purdue Research Foundation | Chimeric antigen receptor-expressing t cells as anti-cancer therapeutics |
| KR102271498B1 (ko) | 2013-08-30 | 2021-07-05 | 보드 오브 리전츠, 더 유니버시티 오브 텍사스 시스템 | 종양 치료를 위한 키누레닌 고갈 효소의 투여 |
| EP3186371B1 (en) * | 2014-08-29 | 2024-08-14 | Board of Regents, The University of Texas System | Administration of kynurenine depleting enzymes for tumor therapy |
| BR112017007765B1 (pt) | 2014-10-14 | 2023-10-03 | Halozyme, Inc | Composições de adenosina deaminase-2 (ada2), variantes do mesmo e métodos de usar o mesmo |
| JP2018510652A (ja) * | 2015-03-18 | 2018-04-19 | ベイラー カレッジ オブ メディスンBaylor College Of Medicine | Her2/erbb2キメラ抗原受容体 |
| EP3402498A1 (en) | 2016-01-11 | 2018-11-21 | Synlogic, Inc. | Microorganisms programmed to produce immune modulators and anti-cancer therapeutics in tumor cells |
| EP3423483B1 (en) * | 2016-03-02 | 2025-09-24 | Board Of Regents Of the University Of Texas System | Human kynureninase enzyme variants having improved pharmacological properties |
| EP3439675A4 (en) | 2016-04-08 | 2019-12-18 | Purdue Research Foundation | METHOD AND COMPOSITIONS FOR CAR-T CELL THERAPY |
| JP7623784B2 (ja) | 2016-10-13 | 2025-01-29 | ジュノー セラピューティクス インコーポレイテッド | トリプトファン代謝経路調節剤を含む免疫療法の方法および組成物 |
| US11649288B2 (en) | 2017-02-07 | 2023-05-16 | Seattle Children's Hospital | Phospholipid ether (PLE) CAR T cell tumor targeting (CTCT) agents |
| WO2018160622A1 (en) | 2017-02-28 | 2018-09-07 | Endocyte, Inc. | Compositions and methods for car t cell therapy |
| JP2020527025A (ja) * | 2017-07-12 | 2020-09-03 | シンロジック オペレーティング カンパニー インコーポレイテッド | 腫瘍細胞において免疫モジュレーターおよび抗がん治療剤を産生するようにプログラムされた微生物 |
| WO2019089740A1 (en) * | 2017-11-03 | 2019-05-09 | Dana-Farber Cancer Institute, Inc. | Biomarkers of clinical response and benefit to immune checkpoint inhibitor therapy |
| US11311576B2 (en) | 2018-01-22 | 2022-04-26 | Seattle Children's Hospital | Methods of use for CAR T cells |
| US12312416B2 (en) | 2018-02-06 | 2025-05-27 | Seattle Children's Hospital | Fluorescein-specific cars exhibiting optimal t cell function against FL-PLE labelled tumors |
| AU2019225174B2 (en) | 2018-02-23 | 2025-11-20 | Endocyte, Inc. | Sequencing method for CAR T cell therapy |
| BR112020020772A2 (pt) | 2018-04-16 | 2021-02-02 | Board Of Regents, The University Of Texas System | enzimas quinureninase humana e usos das mesmas |
| CN110412179A (zh) * | 2018-04-26 | 2019-11-05 | 缪荣明 | 一种液相色谱检测颗粒酶a的方法 |
| EP3893923A2 (en) * | 2018-12-14 | 2021-10-20 | Autolus Limited | Cell |
| CN114828863A (zh) * | 2019-10-17 | 2022-07-29 | 医肯纳肿瘤学公司 | 聚乙二醇化犬尿氨酸酶以及其用于治疗癌症的用途 |
| CN115210252A (zh) | 2020-02-04 | 2022-10-18 | 西雅图儿童医院(Dba西雅图儿童研究所) | 抗二硝基苯酚的嵌合抗原受体 |
| WO2023229024A1 (ja) * | 2022-05-27 | 2023-11-30 | 富士フイルム株式会社 | 血液腫瘍の診断を補助する方法、血液腫瘍の診断を行うためのデータを得る方法、及びこれらの方法のためのキット |
| WO2024085280A1 (ko) * | 2022-10-20 | 2024-04-25 | 서울대학교 산학협력단 | 신규한 키뉴레니나제 및 이의 용도 |
Citations (15)
| Publication number | Priority date | Publication date | Assignee | Title |
|---|---|---|---|---|
| US4870287A (en) | 1988-03-03 | 1989-09-26 | Loma Linda University Medical Center | Multi-station proton beam therapy system |
| US5739169A (en) | 1996-05-31 | 1998-04-14 | Procept, Incorporated | Aromatic compounds for inhibiting immune response |
| US5760395A (en) | 1996-04-18 | 1998-06-02 | Universities Research Assoc., Inc. | Method and apparatus for laser-controlled proton beam radiology |
| US5801005A (en) | 1993-03-17 | 1998-09-01 | University Of Washington | Immune reactivity to HER-2/neu protein for diagnosis of malignancies in which the HER-2/neu oncogene is associated |
| US5824311A (en) | 1987-11-30 | 1998-10-20 | Trustees Of The University Of Pennsylvania | Treatment of tumors with monoclonal antibodies against oncogene antigens |
| US5830880A (en) | 1994-08-26 | 1998-11-03 | Hoechst Aktiengesellschaft | Gene therapy of tumors with an endothelial cell-specific, cell cycle-dependent active compound |
| US5846945A (en) | 1993-02-16 | 1998-12-08 | Onyx Pharmaceuticals, Inc. | Cytopathic viruses for therapy and prophylaxis of neoplasia |
| US5889155A (en) | 1992-08-05 | 1999-03-30 | Genentech, Inc. | Carbohydrate-directed cross-linking reagents |
| US7109304B2 (en) | 2003-07-31 | 2006-09-19 | Immunomedics, Inc. | Humanized anti-CD19 antibodies |
| US20090304666A1 (en) | 2003-06-17 | 2009-12-10 | The Board Of Regents Of The University Of Oklahoma | Conjugate for the specific targeting of anticancer agents to tumor cells or tumor vasculature and production thereof |
| WO2012031744A1 (en) | 2010-09-08 | 2012-03-15 | Chemotherapeutisches Forschungsinstitut | Chimeric antigen receptors with an optimized hinge region |
| WO2012079000A1 (en) | 2010-12-09 | 2012-06-14 | The Trustees Of The University Of Pennsylvania | Use of chimeric antigen receptor-modified t cells to treat cancer |
| WO2012099441A2 (ko) * | 2011-01-21 | 2012-07-26 | 인제대학교산학협력단 | 트립토판 대사효소 유전자를 발현하는 줄기세포를 함유하는 면역 반응 억제용 조성물 |
| WO2013059593A1 (en) | 2011-10-20 | 2013-04-25 | The United States Of America, As Represented By The Secretary, Department Of Health And Human Services | Anti-cd22 chimeric antigen receptors |
| US8465743B2 (en) | 2009-10-01 | 2013-06-18 | The United States Of America, As Represented By The Secretary, Department Of Health And Human Services | Anti-vascular endothelial growth factor receptor-2 chimeric antigen receptors and use of same for the treatment of cancer |
Family Cites Families (15)
| Publication number | Priority date | Publication date | Assignee | Title |
|---|---|---|---|---|
| US6812339B1 (en) * | 2000-09-08 | 2004-11-02 | Applera Corporation | Polymorphisms in known genes associated with human disease, methods of detection and uses thereof |
| US20030194721A1 (en) | 2001-09-19 | 2003-10-16 | Incyte Genomics, Inc. | Genes expressed in treated foam cells |
| JP2005516605A (ja) | 2002-02-01 | 2005-06-09 | ミレニアム・ファーマシューティカルズ・インコーポレイテッド | 心血管疾患を処置するための方法および組成物 |
| CN1330774C (zh) * | 2002-03-01 | 2007-08-08 | 国家人类基因组南方研究中心 | 犬尿氨酸水解酶多态性及其用途 |
| US7714139B2 (en) | 2003-03-27 | 2010-05-11 | Lankenau Institute For Medcial Research | IDO inhibitors and methods of use |
| JP2008237022A (ja) | 2005-06-30 | 2008-10-09 | Osaka Prefecture | 非小細胞肺がんの予防・治療剤および診断薬 |
| WO2008036642A2 (en) * | 2006-09-19 | 2008-03-27 | Incyte Corporation | N-hydroxyamidinoheterocycles as modulators of indoleamine 2,3-dioxygenase |
| GB0625310D0 (en) * | 2006-12-19 | 2007-01-24 | Bioalvo | Yeast platform construction and screening methods |
| KR20120085209A (ko) * | 2011-01-21 | 2012-07-31 | 인제대학교 산학협력단 | 트립토판 대사효소 유전자를 발현하는 줄기세포를 함유하는 면역 반응 억제용 조성물 |
| US9593062B2 (en) * | 2011-09-07 | 2017-03-14 | Deutschland Krebsforschungszentrum | Means and methods for treating and/or preventing natural AHR ligand-dependent cancer |
| KR102271498B1 (ko) * | 2013-08-30 | 2021-07-05 | 보드 오브 리전츠, 더 유니버시티 오브 텍사스 시스템 | 종양 치료를 위한 키누레닌 고갈 효소의 투여 |
| EP3186371B1 (en) | 2014-08-29 | 2024-08-14 | Board of Regents, The University of Texas System | Administration of kynurenine depleting enzymes for tumor therapy |
| EP3423483B1 (en) | 2016-03-02 | 2025-09-24 | Board Of Regents Of the University Of Texas System | Human kynureninase enzyme variants having improved pharmacological properties |
| JP6912171B2 (ja) * | 2016-09-15 | 2021-07-28 | 株式会社トプコン | 眼科検査装置 |
| BR112020020772A2 (pt) | 2018-04-16 | 2021-02-02 | Board Of Regents, The University Of Texas System | enzimas quinureninase humana e usos das mesmas |
-
2014
- 2014-08-29 KR KR1020167008486A patent/KR102271498B1/ko active Active
- 2014-08-29 BR BR112016004095A patent/BR112016004095A2/pt not_active Application Discontinuation
- 2014-08-29 US US14/473,040 patent/US9808486B2/en active Active
- 2014-08-29 AU AU2014312119A patent/AU2014312119B2/en active Active
- 2014-08-29 EP EP18204264.8A patent/EP3492094A1/en not_active Withdrawn
- 2014-08-29 ES ES14840339T patent/ES2707711T3/es active Active
- 2014-08-29 CN CN202111132607.1A patent/CN113957061A/zh active Pending
- 2014-08-29 CN CN201480053899.1A patent/CN105722522B/zh active Active
- 2014-08-29 JP JP2016537898A patent/JP6307163B2/ja active Active
- 2014-08-29 CA CA3173052A patent/CA3173052A1/en active Pending
- 2014-08-29 WO PCT/US2014/053437 patent/WO2015031771A2/en not_active Ceased
- 2014-08-29 KR KR1020217019661A patent/KR102442231B1/ko active Active
- 2014-08-29 CA CA2922670A patent/CA2922670C/en active Active
- 2014-08-29 EP EP14840339.7A patent/EP3038636B1/en active Active
-
2016
- 2016-02-28 IL IL244312A patent/IL244312B/en active IP Right Grant
- 2016-03-02 ZA ZA2016/01443A patent/ZA201601443B/en unknown
- 2016-11-14 US US15/351,060 patent/US20170056449A1/en not_active Abandoned
-
2018
- 2018-03-09 JP JP2018042760A patent/JP7029316B2/ja active Active
-
2019
- 2019-02-19 IL IL264901A patent/IL264901B/en active IP Right Grant
- 2019-04-02 US US16/373,588 patent/US10772913B2/en active Active
-
2020
- 2020-04-16 JP JP2020073212A patent/JP2020111611A/ja not_active Withdrawn
- 2020-08-18 US US16/996,806 patent/US11534463B2/en active Active
-
2022
- 2022-08-23 JP JP2022132161A patent/JP2022159570A/ja active Pending
- 2022-12-13 US US18/065,451 patent/US20240091258A1/en active Pending
Patent Citations (15)
| Publication number | Priority date | Publication date | Assignee | Title |
|---|---|---|---|---|
| US5824311A (en) | 1987-11-30 | 1998-10-20 | Trustees Of The University Of Pennsylvania | Treatment of tumors with monoclonal antibodies against oncogene antigens |
| US4870287A (en) | 1988-03-03 | 1989-09-26 | Loma Linda University Medical Center | Multi-station proton beam therapy system |
| US5889155A (en) | 1992-08-05 | 1999-03-30 | Genentech, Inc. | Carbohydrate-directed cross-linking reagents |
| US5846945A (en) | 1993-02-16 | 1998-12-08 | Onyx Pharmaceuticals, Inc. | Cytopathic viruses for therapy and prophylaxis of neoplasia |
| US5801005A (en) | 1993-03-17 | 1998-09-01 | University Of Washington | Immune reactivity to HER-2/neu protein for diagnosis of malignancies in which the HER-2/neu oncogene is associated |
| US5830880A (en) | 1994-08-26 | 1998-11-03 | Hoechst Aktiengesellschaft | Gene therapy of tumors with an endothelial cell-specific, cell cycle-dependent active compound |
| US5760395A (en) | 1996-04-18 | 1998-06-02 | Universities Research Assoc., Inc. | Method and apparatus for laser-controlled proton beam radiology |
| US5739169A (en) | 1996-05-31 | 1998-04-14 | Procept, Incorporated | Aromatic compounds for inhibiting immune response |
| US20090304666A1 (en) | 2003-06-17 | 2009-12-10 | The Board Of Regents Of The University Of Oklahoma | Conjugate for the specific targeting of anticancer agents to tumor cells or tumor vasculature and production thereof |
| US7109304B2 (en) | 2003-07-31 | 2006-09-19 | Immunomedics, Inc. | Humanized anti-CD19 antibodies |
| US8465743B2 (en) | 2009-10-01 | 2013-06-18 | The United States Of America, As Represented By The Secretary, Department Of Health And Human Services | Anti-vascular endothelial growth factor receptor-2 chimeric antigen receptors and use of same for the treatment of cancer |
| WO2012031744A1 (en) | 2010-09-08 | 2012-03-15 | Chemotherapeutisches Forschungsinstitut | Chimeric antigen receptors with an optimized hinge region |
| WO2012079000A1 (en) | 2010-12-09 | 2012-06-14 | The Trustees Of The University Of Pennsylvania | Use of chimeric antigen receptor-modified t cells to treat cancer |
| WO2012099441A2 (ko) * | 2011-01-21 | 2012-07-26 | 인제대학교산학협력단 | 트립토판 대사효소 유전자를 발현하는 줄기세포를 함유하는 면역 반응 억제용 조성물 |
| WO2013059593A1 (en) | 2011-10-20 | 2013-04-25 | The United States Of America, As Represented By The Secretary, Department Of Health And Human Services | Anti-cd22 chimeric antigen receptors |
Non-Patent Citations (54)
| Title |
|---|
| "Genbank", Database accession no. EHH54849.1 |
| "Genbank", Database accession no. XP 002812508.1 |
| "Genbank", Database accession no. XP 003309314.1 |
| "Remington's Pharmaceutical Sciences", 1990 |
| "Remington's Pharmaceutical Sciences", 1990, MACK PRINTING COMPANY, pages: 1289 - 1329 |
| AHMED ET AL.: "HER2-specific T cells target primary glioblastoma stem cells and induce regression of autologous experimental tumors", CLINICAL CANCER RESEARCH, vol. 16, no. 2, 2010, pages 474 - 485, XP055489972, DOI: doi:10.1158/1078-0432.CCR-09-1322 |
| ALBERATI-GIANI D ET AL: "Isolation and expression of a cDNA clone encoding human kynureninase", EUROPEAN JOURNAL OF BIOCHEMISTRY, WILEY-BLACKWELL PUBLISHING LTD, GB, vol. 239, no. 2, 1 January 1996 (1996-01-01), pages 460 - 468, XP002376377, ISSN: 0014-2956, DOI: 10.1111/J.1432-1033.1996.0460U.X * |
| AUSTIN-WARD; VILLASECA, REVISTA MEDICA DE CHILE, vol. 126, no. 7, 1998, pages 838 - 845 |
| AUSUBEL ET AL.: "Current Protocols in Molecular Biology", 1994, GREENE PUBLISHING ASSOCIATES AND WILEY INTERSCIENCE |
| BUKOWSKI ET AL., CLINICAL CANCER RES., vol. 4, no. 10, 1998, pages 2337 - 2347 |
| CHEN; GUILLEMIN: "Kynurenine pathway metabolites in humans: disease and healthy States", INT J TRYPTOPHAN RES, vol. 2, 2009, pages 1 - 19, XP055294578, DOI: doi:10.4137/IJTR.S2097 |
| CHRISTODOULIDES ET AL., MICROBIOLOGY, vol. 144, 1998, pages 3027 - 3037 |
| CURRAN ET AL.: "PD-1 and CTLA-4 combination blockade expands infiltrating T cells and reduces regulatory T and myeloid cells within B 16 melanoma tumors", PROCEEDINGS OF THE NATIONAL ACADEMY OF SCIENCES, vol. 107, 2010, pages 4275 - 4280, XP055067204, DOI: doi:10.1073/pnas.0915174107 |
| DAVIDSON ET AL., J. IMMUNOTHER., vol. 21, no. 5, 1998, pages 389 - 398 |
| DE JONG ET AL.: "Serum tryptophan and kynurenine concentrations as parameters for indoleamine 2,3-dioxygenase activity in patients with endometrial, ovarian, and vulvar cancer", INT J GYNECOL CANCER, vol. 21, no. 7, 2011, pages 1320 - 1327 |
| DELLA CHIESA ET AL.: "The tryptophan catabolite L-kynurenine inhibits the surface expression of NKp46-and NKG2D-activating receptors and regulates NK-cell function", BLOOD, vol. 108, no. 13, 2006, pages 4118 - 4125 |
| GODIN-ETHIER ET AL.: "Indoleamine 2, 3-Dioxygenase Expression in Human Cancers: Clinical and Immunologic Perspectives", CLINICAL CANCER RESEARCH, vol. 17, no. 22, 2011, pages 6985 - 6991, XP055273303, DOI: doi:10.1158/1078-0432.CCR-11-1331 |
| HANIBUCHI ET AL., INT. J. CANCER, vol. 78, no. 4, 1998, pages 480 - 485 |
| HARKKI ET AL., BIOTECHNOLOGY, vol. 7, 1989, pages 596 - 603 |
| HAROLD A. WALSH ET AL: "Purification and biochemical characterizaton of some of the properties of recombinant human kynureninase", EUROPEAN JOURNAL OF BIOCHEMISTRY, vol. 269, 9 April 2002 (2002-04-09), pages 2069 - 2074, XP002790553, DOI: https://doi.org/10.1046/j.1432-1033.2002.02854 * |
| HELLSTRAND ET AL., ACTA ONCOLOGICA, vol. 37, no. 4, 1998, pages 347 - 353 |
| HOLLANDER, FRONT. IMMUN., vol. 3, 2012, pages 3 |
| HOLMGAARD ET AL.: "Indoleamine 2, 3-dioxygenase is a critical resistance mechanism in antitumor T cell immunotherapy targeting CTLA-4", THE JOURNAL OF EXPERIMENTAL MEDICINE, vol. 210, 2013, pages 1389 - 1402, XP002770451, DOI: doi:10.1084/jem.20130066 |
| HOOVER; LUBKOWSKI: "DNAWorks: an automated method for designing oligonucleotides for PCR-based gene synthesis", NUCLEIC ACIDS RESEARCH, vol. 30, no. 10, 2002, pages e43 - e43 |
| HOPWOOD ET AL.: "A Laboratory Manual", 1985, THE JOHN INNES FOUNDATION, article "Genetic Manipulation of Streptomyces" |
| HUI; HASHIMOTO, INFECTION IMMUN., vol. 66, no. 11, 1998, pages 5329 - 5336 |
| ITO ET AL., J. BIOCHEM., vol. 79, 1976, pages 1263 |
| KAPER ET AL.: "Nanosensor detection of an immunoregulatory tryptophan influx/kynurenine efflux cycle", PLOSBIOLOGY, vol. 5, no. 10, 2007, pages e257 |
| LIPOWSKA-BHALLA ET AL.: "Targeted immunotherapy of cancer with CAR T cells: achievements and challenges", CANCER IMMUNOLOGY IMMUNOTHERAPY, vol. 61, no. 7, 2012, pages 953 - 962, XP035074376, DOI: doi:10.1007/s00262-012-1254-0 |
| LOB ET AL.: "Inhibitors of indoleamine-2,3-dioxygenase for cancer therapy: can we see the wood for the trees?", NAT REV CANCER, vol. 9, no. 6, 2009, pages 445 - 452, XP055203135 |
| LORDANESCU, J. BACTERIOL, vol. 12, 1975, pages 597 601 |
| MANDI; VECSEI: "The kynurenine system and immunoregulation", J NEURAL TRANSM, vol. 119, no. 2, 2012, pages 197 - 209, XP035007009, DOI: doi:10.1007/s00702-011-0681-y |
| MANIATIS ET AL.: "Molecular Cloning, A Laboratory Manual", 1988, COLD SPRING HARBOR PRESS |
| MELLOR ET AL., GENE, vol. 24, 1983, pages 1 - 14 |
| MEZRICH ET AL.: "An interaction between kynurenine and the aryl hydrocarbon receptor can generate regulatory T cells", THE JOURNAL OF IMMUNOLOGY, vol. 185, no. 6, 2010, pages 3190 - 3198 |
| OPITZ ET AL.: "An endogenous tumour-promoting ligand of the human aryl hydrocarbon receptor", NATURE, vol. 478, no. 7368, 2011, pages 197 - 203, XP055045387, DOI: doi:10.1038/nature10491 |
| OPITZ ET AL.: "The Indoleamine-2, 3-Dioxygenase (IDO) Inhibitor I-Methyl-D-tryptophan Upregulates IDOl in Human Cancer Cells", PLOS ONE, vol. 6, no. 5, 2011, pages el9823 |
| PENTTILA ET AL., GENE, vol. 61, 1987, pages 155 - 164 |
| PHILLIPS ROBERT S ED - VALPUESTA JOS� M ET AL: "Structure and mechanism of kynureninase", ARCHIVES OF BIOCHEMISTRY AND BIOPHYSICS, ACADEMIC PRESS, US, vol. 544, 4 November 2013 (2013-11-04), pages 69 - 74, XP028829902, ISSN: 0003-9861, DOI: 10.1016/J.ABB.2013.10.020 * |
| PILOTTE ET AL.: "Reversal of tumoral immune resistance by inhibition of tryptophan 2,3-dioxygenase.", PROC NATL ACAD SCI USA, vol. 109, no. 7, 2012, pages 2497 - 2502, XP055219624, DOI: doi:10.1073/pnas.1113873109 |
| PRENDERGAST: "Cancer: Why tumours eat tryptophan", NATURE, vol. 478, no. 7368, 2011, pages 192 - 194 |
| QIN ET AL., PROC. NATL. ACAD. SCI. USA, vol. 95, no. 24, 1998, pages 14411 - 14416 |
| RUTELLA ET AL.: "Targeting indoleamine 2,3-dioxygenase (IDO) to counteract tumour-induced immune dysfunction: from biochemistry to clinical development", ENDOCR METAB IMMUNE DISORD DRUG TARGETS, vol. 9, no. 2, 2009, pages 151 - 177, XP009120575, DOI: doi:10.2174/187153009788452453 |
| S. TOMA ET AL: "Cloning and recombinant expression of rat and human kynureninase", FEBS LETTERS, vol. 408, no. 1, 12 May 1997 (1997-05-12), pages 5 - 10, XP002768216, ISSN: 0014-5793 * |
| SANTIAGO LIMA ET AL: "Crystal Structure of Homo sapiens Kynureninase", BIOCHEMISTRY, vol. 46, no. 10, 1 March 2007 (2007-03-01), US, pages 2735 - 2744, XP055354311, ISSN: 0006-2960, DOI: 10.1021/bi0616697 * |
| SCHELLENBERGER ET AL., NATURE BIOTECH., vol. 27, 2009, pages 1186 - 1190 |
| SHIN ET AL.: "Modulation of natural killer cell antitumor activity by the aryl hydrocarbon receptor", PROC NATL ACAD SCI USA, vol. 110, no. 30, 2013, pages 12391 - 12396 |
| SIBAKOV ET AL., EUR. J. BIOCHEM., vol. 145, 1984, pages 567 572 |
| SONG ET AL.: "L-Kynurenine-induced apoptosis in human NK cells is mediated by reactive oxygen species", INTERNATIONALIMMUNOPHARMACOLOGY, vol. 11, no. 8, 2011, pages 932 - 938, XP028237816, DOI: doi:10.1016/j.intimp.2011.02.005 |
| STONE ET AL.: "Replacing Mn2+ with Co2+ in human arginase I enhances cytotoxicity toward L-arginine auxotrophic cancer cell lines", ACS CHEMICAL BIOLOGY, vol. 5, 2010, pages 333 - 342 |
| WARD, PROC, EMBO-ALKO WORKSHOP ON MOLECULAR BIOLOGY OF FILAMENTOUS FUNGI, 1989, pages 119 - 128 |
| WAWRZYNCZAK; THORPE: "Immunoconjugates, Antibody Conuugates In Radioimaging And Therapy Of Cancer", vol. 28, 1987, OXFORD UNIVERSITY PRESS |
| YAO ET AL.: "Serum metabolic profiling and features of papillary thyroid carcinoma and nodular goiter", MOL BIOSYST, vol. 7, no. 9, 2011, pages 2608 - 2614 |
| YOSHIKAWA ET AL.: "Serum concentration of L-kynurenine predicts the clinical outcome of patients with diffuse large B-cell lymphoma treated with R-CHOP", EUR J HAEMATOL, vol. 84, no. 4, 2010, pages 304 - 309, XP009172410, DOI: doi:10.1111/j.1600-0609.2009.01393.x |
Also Published As
Similar Documents
| Publication | Publication Date | Title |
|---|---|---|
| US20240091258A1 (en) | Administration of kynurenine depleting enzymes for tumor therapy | |
| US11168142B2 (en) | Administration of kynurenine depleting enzymes for tumor therapy | |
| US10716856B2 (en) | Engineered primate cystine/cysteine degrading enzymes as antineogenic agents | |
| EP3039139B1 (en) | Engineered primate l-methioninase for therapeutic purposes | |
| US20230227796A1 (en) | Enzyme-mediated depletion of adenosine and/or methylthioadenosine | |
| HK1226335B (en) | Administration of kynurenine depleting enzymes for tumor therapy | |
| HK1226335A1 (en) | Administration of kynurenine depleting enzymes for tumor therapy | |
| NZ717492B2 (en) | Administration of kynurenine depleting enzymes for tumor therapy |
Legal Events
| Date | Code | Title | Description |
|---|---|---|---|
| PUAI | Public reference made under article 153(3) epc to a published international application that has entered the european phase |
Free format text: ORIGINAL CODE: 0009012 |
|
| STAA | Information on the status of an ep patent application or granted ep patent |
Free format text: STATUS: THE APPLICATION HAS BEEN PUBLISHED |
|
| AC | Divisional application: reference to earlier application |
Ref document number: 3038636 Country of ref document: EP Kind code of ref document: P |
|
| AK | Designated contracting states |
Kind code of ref document: A1 Designated state(s): AL AT BE BG CH CY CZ DE DK EE ES FI FR GB GR HR HU IE IS IT LI LT LU LV MC MK MT NL NO PL PT RO RS SE SI SK SM TR |
|
| STAA | Information on the status of an ep patent application or granted ep patent |
Free format text: STATUS: REQUEST FOR EXAMINATION WAS MADE |
|
| 17P | Request for examination filed |
Effective date: 20191204 |
|
| RBV | Designated contracting states (corrected) |
Designated state(s): AL AT BE BG CH CY CZ DE DK EE ES FI FR GB GR HR HU IE IS IT LI LT LU LV MC MK MT NL NO PL PT RO RS SE SI SK SM TR |
|
| STAA | Information on the status of an ep patent application or granted ep patent |
Free format text: STATUS: EXAMINATION IS IN PROGRESS |
|
| 17Q | First examination report despatched |
Effective date: 20221104 |
|
| STAA | Information on the status of an ep patent application or granted ep patent |
Free format text: STATUS: THE APPLICATION IS DEEMED TO BE WITHDRAWN |
|
| 18D | Application deemed to be withdrawn |
Effective date: 20251028 |